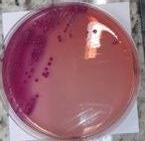
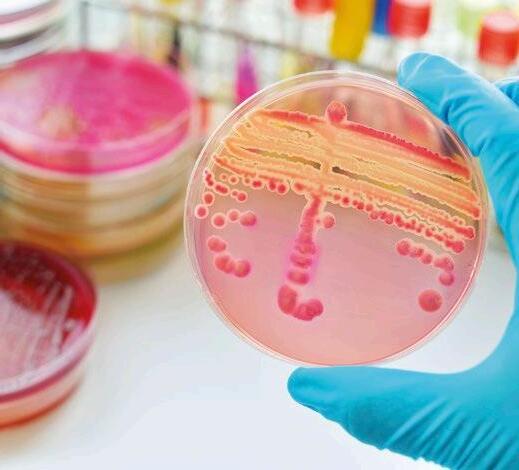

TEMPORIZACIÓN DE LOS PANELES DE ENFRIAMIENTO EVAPORATIVO





![]()





Gases efecto invernadero y ganadería: ciencia frente a titulares alarmistas 06

Juan Pascual
VP Elanco Francia, Iberia & Italia
Alerta en seguridad alimentaria: la presencia de cloratos 16

José Luis Valls García
Director técnico de aviNews España

Empresas conscientes: estrategias gerenciales para aumentar la productividad, mejorando el bienestar del personal que labora en la prefaena y el procesamiento
Eduardo Cervantes López Consultoría Internacional - Gerencia Productiva e Innovadora en Procesamiento de Aves

Temporización de los paneles de enfriamiento evaporativo

Michael Czarick
Extension Engineer Departament of Poultry Science - University Georgia
Traductor: Serafín García Freire
Elaboración de pollo entero condimentado
Leonardo Ortiz Escoto Gerente general Improasa
Infección por estafilococo en la población de reproductoras
Eric L. Jensen1 y Dra. Carolyn L. Miller2
1DVM, MAM, diplomado de la ACPV, 2DVM, MAM, diplomada de la ACPV (2001). Revisado por Jose J. Bruzual
DVM, MAM, MSc, diplomado del APCV, PAS

Bacterias en la planta de incubación: impacto y estrategias de control
Renata Steffen
Consultora Avícola
El huevo como alimento funcional y sus componentes 68 84
La importancia real de los niveles de las unidades formadoras de placas (UFP) en las vacunas de marek
Isabel M. Gimeno
DVM, PhD, Profesora, Universidad estatal de Carolina del Norte
2027 está a la vuelta de la esquina, di adiós a las jaulas 78
Contenido del equipo técnico de SKA

Alphitobius diaperinus: un problema en la avicultura
Alice Silva Veterinaria Lusiaves

Salud digestiva en avicultura: estrategias integrales y el rol de Bilantul, solución para optimizar el rendimiento productivo 94
Pedro Gil Sevillano
Veterinario Consultor
Gestión de los riesgos asociados a Histomonas y coccidios mediante plantas y sustancias aromáticas
J.M. Watier2 , A. Mahieu2*, A. Canin2 , R. Domitile2 , M. Aoun2 , F. Laurent1 , D. Liebhart 3 , M. Hess 3 , A. Greuter2
1INRAE, Universidad de Tours, ISP, equipo
AIM, F-37380, Nouzilly, Francia
2IDENA, 21, rue du moulin, F-44880, Sautron, Francia
3Vetmeduni, Vienne, Universidad de Veterinaria, Veterinärplatz 1, A - 1210 Wien, Austria
Laura Rodríguez
Departamento Técnico de AMBiotec
Alimentación de ponedoras de larga vida productiva 122

Manuel Vázquez
Ing. Agr. Msc, Nutricionista





Nos encontramos en un momento crucial, con grandes retos comerciales, ambientales, de bienestar animal, de sostenibilidad y de reputación de un sector. Además el sector avícola sigue siendo uno de los grandes aliados de la lucha contra la despoblación, porque por sus empleos directos y por los indirectos se han creado y mantenido especialmente en las zonas rurales muchos puestos de trabajo en zonas donde se vertebra al sector ganadero y la industria avícola.
En el complejo entramado del sistema agroalimentario español, el sector avícola ocupa un lugar estratégico que, aunque a menudo pasa desapercibido en el debate público, es clave para la seguridad alimentaria, la sostenibilidad medioambiental, la innovación, la garantía del abastecimiento a la población, la inversión constante y el empleo, la estabilidad económica rural y la sostenibilidad del modelo productivo nacional.
España es uno de los principales productores avícolas de la Unión Europea. Con más de 700 millones de aves producidas anualmente la avicultura no solo garantiza el acceso a una fuente de proteína asequible, nutritiva y barata sino que también es responsable de una parte significativa del empleo y del valor añadido generado en el campo español.
La estructura del sector, formado mayoritariamente por explotaciones familiares integradas, ha demostrado una gran capacidad de adaptación, eficiencia y resiliencia. Durante las recientes crisis sanitarias y logísticas, la avicultura fue uno de los pocos sectores que mantuvo un suministro estable y continuo a la población, incluso en momentos de alta presión como la pandemia o el alza de los precios de los piensos.
Además, España se ha consolidado como un vendedor intracomunitario de productos avícolas y un exportador relevante , especialmente en mercados extracomunitarios como Asia y África, gracias a su alto estándar sanitario y a la calidad de sus procesos productivos. Este posicionamiento, sin embargo, requiere un apoyo constante en innovación, bioseguridad y apertura de nuevos mercados.
En términos medioambientales, el sector avícola español también enfrenta grandes retos:
La gestión sostenible de residuos, La huella de carbono
El uso eficiente del agua
El uso de los recursos
Son ya elementos estratégicos para garantizar no solo la rentabilidad, sino también la aceptación social de la actividad. La inversión en tecnología, digitalización y bienestar animal no puede ser vista como un lujo, sino como un imperativo de competitividad y reputación.
Por ello, urge que las políticas públicas reconozcan de forma clara y efectiva el valor estratégico de la avicultura española. Esto implica facilitar el acceso a financiación verde, reforzar los mecanismos de sanidad animal y control veterinario, promover la formación técnica, y asegurar un marco normativo estable que no penalice al productor frente a la competencia internacional.
El futuro del campo español pasa, entre otros sectores clave, por una avicultura fuerte, moderna, sostenible y reconocida. No es solo una cuestión de economía o salud pública, es una cuestión de visión de país.
EDITOR
GRUPO DE COMUNICACIÓN AGRINEWS S.L.
PUBLICIDAD
Luis Carrasco +34 605 09 05 13 lc@agrinews.es
Félix Muñoz +34 618 18 00 16 felix@mediatarsis.com
DIRECCIÓN TÉCNICA
José Luis Valls
REDACCIÓN
Gerard Ponz
Daniela Morales F.X. Mora
COLABORADORES
José Ignacio Barragán
Luis Canela
Serafín García Freire
Edgar Oviedo Rondón
Juan Carlos López
Mike Czarick
Santiago Vega
Juan Carlos Abad
Eduardo Cervantes
Gonzalo González Mateos
Barcelona - España
Tel: +34 93 115 44 15 info@agrinews.es avinews.com
Precio de suscripción anual: España 36 € Extranjero 125 €
DIRIGIDA A VETERINARIOS Y TÉCNICOS
Depósito Legal aviNews B11597-2013
ISSN (Revista impresa) 2696-8061
ISSN (Revista digital) 2696-807X
Revista bimestral
La dirección de la revista no se hace responsable de las opiniones de los autores. Todos los derechos reservados. Imágenes: Noun Project / Freepik/Dreamstime
Juan Pascual VP Elanco Francia, Iberia & Italia

La reducción de las emisiones de gases de efecto invernadero (GEI) se ha convertido en un objetivo social, político y mediático de primer orden.
Los esfuerzos en esa dirección son denodados en todas las industrias y la ganadería no es una excepción.
Máxime cuando ésta es frecuentemente acusada en los titulares de prensa de ser una de las principales emisoras de GEI. Esto ha llevado a no pocos dirigentes políticos a enfocar en ella legislaciones restrictivas.

Un ejemplo de ello es la reciente aprobación en Dinamarca del primer impuesto mundial a las emisiones del ganado.
Otro caso es la restricción del consumo de carne impuesta por numerosas corporaciones municipales europeas y norteamericanas en los menús escolares.
Vayamos a las fuentes de autoridad científica sobre las emisiones para intentar separar el trigo de la paja, ver cuál es el nivel de emisiones real de las distintas especies ganaderas, en qué regiones del mundo se emite más y qué soluciones proponen los organismos que mejor conocen este aspecto para reducirlas y alcanzar los objetivos del 2050.

La referencia mundial sobre emisiones la ostenta el Panel Intergubernamental sobre el Cambio Climático (IPCC en inglés).
Organismo dependiente de la ONU que recoge trabajos científicos sobre este aspecto de todos los sectores. Quien aporta la información sobre las emisiones ganaderas al IPCC es la FAO.
Según este organismo, las emisiones globales tanto directas como indirectas - este es un matiz muy importante - con origen en los animales de producción son de un 12%1

Fig 1: Web de la FAO en la que se muestra el último dato relativo a las emisiones ganaderas mundiales, 12% del total, homogéneamente distribuidas entre directas e indirectas.
Estas emisiones son muy variadas según especies. Esta gráfica, también de la FAO, lo demuestra.
Además, como podemos ver en este gráfico del mismo organismo, las emisiones son muy heterogéneas en función de la región que analicemos.
Así, para una producción de proteína animal prácticamente idéntica, América Latina emite algo más del doble que Europa Occidental.
animal (dcha) y emisiones asociadas a las mismas (izda) por regiones
2. Emisiones totales y relativas de cada especie ganadera2

Por ello, cuando hablemos de emisiones del ganado dar un dato sin referirse a una especie o región es un sinsentido.

En el seno de la Unión Europea, las emisiones ganaderas se sitúan en torno a un 6%3
Gestión del estiércol
Suelos agrícolas
Fermentación entérica
Cultivo de arroz
Quema de residuos agrícolas en el campo y otros
Fig 4. Distribución de las emisiones totales de gases de efecto invernadero (GEI) por sector. No se incluyen los equivalentes de CO₂ provenientes del Uso de la Tierra, Cambio de Uso de la Tierra y Silvicultura (LULUCF).
Además, conviene tener muy presente que el metano (CH4), el GEI que es responsable de la mayor parte de las emisiones ganaderas, se comporta de un modo muy distinto al CO2 de origen fósil.
El CH4 tiene un poder calórico muy superior al CO2 pero es un gas que desaparece de la atmósfera en unos 10 años y forma parte de un ciclo biogénico.
Es decir, el gas metano emitido por las vacas tiene su origen en los vegetales que consumen.
Una parte de esa celulosa se transforma en CH4 en el rumen y se expele con el eructo. Una vez en la atmósfera se descompondrá en CO2 que, por fotosíntesis, formará nueva celulosa de plantas que serán consumidas por los animales.
Este ciclo es un mecanismo natural que el planeta ha puesto en marcha hace millones de años.




5. Ciclo biogénico del carbono
Muy distinto es el caso del CO2 emitido por los combustibles fósiles.

Este gas no forma parte de ningún ciclo y permanece en la atmósfera durante unos mil años aproximadamente.
El planeta no tiene mecanismos para absorber la enorme cantidad que se emite.



Este importante aspecto no es tenido en cuenta a la hora de medir las emisiones. El IPCC considera al CH4 como un gas con 100 años de vida, pero omite que esa comparación no es la adecuada, tal y como hemos explicado.
Otro punto que tampoco, a día de hoy, considera el IPCC es el secuestro carbono que realizan, especialmente los rumiantes en extensivo, incorporando sus deyecciones en los pastizales..
De todos modos, las mediciones y métodos del IPCC avanzan, se adaptan a los nuevos conocimientos y estoy convencido de que estos aspectos serán, más pronto que tarde, tenidos en cuenta
Veamos ahora qué medidas aconseja la FAO para que el sector pecuario reduzca sus emisiones.
Emisiones proyectadas para 2050 sin mitigación
Emisiones que hoy alcanzan los 6.000 M de TM de CO2 eq y que para el 2050 deben reducirse hasta las 1.9 M TM.
Como verán en la figura siguiente, las 3 actuaciones más relevantes y con mayor impacto para lograr ese objetivo son:
Mejorar la productividad de los animales
Mejorar la genética
Mejorar la sanidad de los animales.
En resumen, de lo que se trata es de producir más con menos, de tener animales más productivos que, con menos insumos, puedan darnos la misma cantidad -o mayor- de leche, carne, huevos o pescado.
Mejoras en la alimentación y nutrición
Mejora de la salud animal Secuestro de carbono Bioeconomía circular Gestión del estiércol
Emisiones proyectadas para 2050 Uso de energía Mejora genética

Y desde luego, en los países altamente tecnificados lo estamos consiguiendo. Veámoslo con 2 ejemplos.
Comparación de la evolución de la producción de leche y carne y la reducción de las emisiones de metano en la UE entre 1990 y 2016 (en megatoneladas de emisiones (CO2eq) procedentes de CH4 y en kg por animal)
Emisiones en megatoneladas (CO2eq) procedentes de CH4 (incl. gestión del estiércol y fermentación entérica)
Evolución de la producción de leche en kg por animal
Producción de carne/peso de la canal en kg por animal
Fig 8. Mayor rendimiento: más producción y menor emisión de gases por kg de output
Un caso paradigmático lo podemos observar en Alemania. Este país ha duplicado su población desde 1893, pero sus emisiones se han mantenido estables.
Hoy, el ganado alemán emite lo mismo que a finales del S.XIX. La razón no es otra que la mejora de la productividad así como la reducción de enfermedades.
Fig 9. Los GEI ganaderos en Alemania son los mismos hoy que en 1893
Es importante transmitir estos datos a la sociedad, de lo contrario, ya hemos visto que se legisla contra los intereses de este sector.
Pero no solo eso, también algunas corporaciones toman decisiones contradictorias.
También resulta contradictorio constatar cómo, por presiones de grupos animalistas -que en general ignoran las aportaciones ecológicas, de salud y sociales que aporta la producción pecuaria- se comienza a observar en algunos países europeos una producción avícola importante de aves de crecimiento lento, asumiendo que así los pollos tienen un mejor bienestar.


Veamos el ejemplo de Virgin Airlines. Esta aerolínea, hace unos pocos meses, celebró alborozada un hito importante: haber llevado a cabo el primer vuelo trasatlántico a base de combustible 100% sostenible8. ¿Cuál fue el combustible utilizado? Pues, en gran parte, grasa de origen animal.
Lo paradójico es que esta misma línea aérea haya retirado la carne de vacuno de sus menús pues -según declara- es poco sostenible mientras los motores de sus aeronaves consumen el equivalente a la grasa de 8.000 cerdos para sobrevolar el Atlántico.
Resulta evidente que, por una parte, mayor tiempo de crianza no es sinónimo de mejor bienestar, pero es que además producir lentamente supone producir menos eficazmente y por lo tanto utilizar más insumos -pienso, agua, energía- y consecuentemente, emitir más.

Resulta imposible defender una cosa (reducir emisiones) y la contraria (producir de modo menos eficiente) y querer tener razón las dos veces.

Sea como fuere, los GEI son una materia importante y debemos explicar y defender el buen hacer del sector en este particular. Porque la ganadería invierte y se esfuerza por reducir su huella de carbono en todos los eslabones de la cadena.
Y los datos son contundentes, como pueden constatar en este gráfico del Ministerio de Transición Ecológica, la reducción de emisiones de GEI del sector ha sido constante desde el año 2005.

Así debe ser, y así se debe seguir trabajando para llegar a cumplir con los objetivos establecidos por la ONU.
Es posible, y el sector lo hará, lo que es imprescindible es que la ciencia se imponga a la ideología que, en ocasiones, conduce a decisiones políticas -o empresarialesdifíciles de comprender para una industria que emite poco -cada vez menos- y que aporta nutrientes imprescindibles e irremplazables para la sociedad.
Resto

Gases efecto invernadero y ganadería: Ciencia frente a titulares alarmistas DESCÁRGALO EN PDF
Usos F-gi
Cultivos
Ganadería
Residuos
Máquina o -road
Transporte carretera
RCI
Industria
Generación eléctrica
José Luis Valls García
Veterinario Consultor Avícola

No ha sido la primera vez, ni probablemente será la última, en la que una gran empresa, en este caso Coca Cola, retira del mercado europeo varios lotes de refrescos como Sprite o Fanta por la presencia excesiva de cloratos.
Una de las últimas acciones de este tipo se llevó a cabo en el mes de enero de este año. Y es que, la conocida multinacional que produce los refrescos, tuvo que retirar del mercado europeo miles de litros tanto en latas como en botellas.
La razón que les llevó a ello fue la detección de una excesiva concentración de cloratos en la bebida que contenían.
No fue una situación de alto riesgo para la salud debido a las dosis detectadas, pero lo cierto es que esta medida de precaución puso sobre la mesa de nuevo la alimentaria y su relevancia.
Asuntos tan importantes como los peligros que amenazan nuestra salud o los riesgos que estamos asumiendo sin saberlo, reaparecen cada cierto tiempo dejando en evidencia la elevada vulnerabilidad en la que vivimos en cuestiones de salud.


lo que hace que su presencia sea una preocupación.
Los cloratos se asocian a actividades humanas. Se emplean como pesticidas, pero desafortunadamente también aparecen como un residuo tóxico por el tratamiento con algunos biocidas para el agua. Los cloratos en el agua pueden representar un problema para la salud y el medioambiente.
Los cloratos se generan principalmente como subproductos de la desinfección del agua potable con dióxido de cloro o por la degradación del hipoclorito de sodio.
Los primeros residuos tóxicos que se producen de ciertos biocidas son por una reacción química de oxidación, formándose los cloritos. Estos pueden oxidarse a cloratos cuando reaccionan con agentes oxidantes como:
Dióxido de cloro ( ClO2 )
Hipoclorito sódico ( NaCIO )
Ozono ( O3 )
Peróxidos ( H2O2 )
El ozono no puede producir cloratos directamente. Sin embargo, en presencia de ciertos compuestos de cloro, como dióxido cloro o hipocloritos puede participar en reacciones químicas que lleven a la formación de cloratos.

Los peróxidos pueden participar en la formación de cloratos bajo ciertas condiciones. La reacción típica ocurre cuando hay iones clorito (ClO2−) o hipoclorito (ClO−) en presencia de peróxidos, especialmente en medios alcalinos.
Por ejemplo, el peróxido de hidrógeno
H2O2 + 2 ClO−
El valor del pH, la concentración de reactivos, el exceso de temperatura y un aumento del tiempo de almacenamiento del agua ayudan a la conversión de cloritos en cloratos.

A priori, la idea de que una sustancia residual tóxica llegue a nuestro paladar y, peor aún, a nuestro estómago, no parece muy agradable.
De hecho, es ciertamente preocupante, pues un consumo excesivo de cloratos bloquea el transporte de yoduro a las células tiroideas mediante la inhibición del transportador NIS (sodio-yoduro symporter).



Esto puede causar una disminución en la producción de hormonas tiroideas y provocar hipotiroidismo.
el contenido de estos compuestos en los alimentos y se establecieron unos límites de seguridad.
Hay que tener en cuenta que la contaminación es debida a procesos de producción, por su presencia en aguas de riego o como productos residuales en las desinfecciones con determinados biocidas clorados.

D E T E RG EN T E S







Descenso de hasta un 90% de la carga microbiana
Perfecta combinación de tensoactivos, hidróxidos, ácidos y secuestrantes para cada aplicación
Degradan biofilms e incrustaciones de sales imposibles de eliminar sólo con agua
Facilitan el aclarado y la desinfección posterior


· Eficacia probada por normas UNE oficiales europeas.
· 100% Estable.
· 100% Biodegradable.
LÍMITES MÁXIMOS DE CLORATO EN ALIMENTOS:
El Reglamento (UE) 2020/749 de la Comisión, de 4 de junio de 2020, modificó el anexo III del Reglamento (CE) nº 396/2005, fijando límites máximos de residuos (LMR) de clorato en una variedad de productos alimenticios. Estos límites son temporales y están sujetos a revisión antes del 8 de junio de 2025.
Los LMR establecidos para los productos de origen animal : (carnes, pescados, productos lácteos): 0,1 mg/kg.
LÍMITES MÁXIMOS DE CLORATOS EN AGUA POTABLE:
La presencia de clorato en el agua potable está regulada por la OMS y la EPA debido a sus efectos negativos en la salud.
La Directiva (UE) 2020/2184 del Parlamento Europeo y del Consejo, de 16 de diciembre de 2020, relativa a la calidad de las aguas destinadas al consumo humano, establece un valor paramétrico para el clorato de 0,25 mg/l.
Sin embargo, cuando se utilizan métodos de desinfección que generan clorato, en particular el dióxido de cloro, se permite un valor paramétrico de hasta 0,7 mg/L.
En estos casos, los Estados miembros deben procurar alcanzar un valor más bajo siempre que sea posible sin comprometer la eficacia de la desinfección.
Es importante destacar que estos límites se han establecido para proteger la salud pública, ya que la exposición prolongada al clorato puede tener efectos adversos, especialmente en poblaciones vulnerables como lactantes y niños pequeños.
Por ello, es fundamental que las industrias alimentarias y las autoridades competentes implementen buenas prácticas de higiene y control para minimizar la presencia de clorato en alimentos y agua.
Sabemos cuál es la horquilla de seguridad en la que se mueven las cantidades de cloratos para que no supongan un peligro. Ahora bien,

¿de dónde viene entonces la preocupación de los expertos? ¿Por qué ha sido necesario establecer esos máximos? ¿De qué nos están protegiendo?
Los cloratos han generado gran preocupación debido a sus posibles efectos adversos en la función tiroidea humana, pudiendo provocar hipotiroidismo, lo que podría afectar al crecimiento y al desarrollo cognitivo en fetos, recién nacidos y niños pequeños.
Pero además, los principales problemas que puede ocasionar su presencia, son:
Efectos en la sangre: Los cloratos pueden afectar la capacidad de los glóbulos rojos para transportar oxígeno, causando metahemoglobinemia, especialmente en niños y personas con deficiencias enzimáticas.
Daño en el sistema nervioso y riñones: La exposición prolongada a niveles elevados puede causar daño renal y neurológico.
Efectos en personas vulnerables: Pacientes con enfermedades hematológicas o renales, niños
Ósmosis inversa: Es uno de los métodos más efectivos para eliminar cloratos.
Filtración con carbón activado: Puede reducir la presencia de estos compuestos.
Reducción del uso de dióxido de cloro y de hipoclorito sódico: Optar por otros biocidas que no produzcan estos residuos tóxicos para desinfección del agua.
El dióxido de cloro (ClO₂)
Es un compuesto químico utilizado como desinfectante del agua y agente


Estos precursores reaccionan con el desinfectante, dando lugar a la aparición de una serie de sustancias indeseables, que en el caso de la desinfección por dióxido de cloro se trata de compuestos orgánicos clorados, muchos de los cuales tienen comprobada su capacidad tóxica y/o mutagénica para el hombre.
Entre los productos de la reacción del dióxido de cloro con material orgánico se encuentran los clorofenoles, ácidos maléicos, fumáricos y oxálicos.
Durante el proceso de oxidación el dióxido de cloro se oxida a ión clorito, que se oxida a clorato.
Los cloratos (ClO₃) se forman como subproductos tóxicos de la descomposición

A concentraciones mayores a 30 mg/L en agua, el dióxido de cloro puede descomponerse de manera significativa, formando cloratos (ClO₃) y cloruros (Cl).
A altas dosis o concentraciones superiores a 100 mg/L, la descomposición aumenta, generando un exceso de cloratos, lo cual es indeseable en aplicaciones de potabilización de agua debido a su toxicidad.

A temperaturas elevadas y pH alcalino (>8.5), la conversión desde el dióxido de cloro a cloratos es más rápida.

El uso de biocida a base de hipoclorito es una práctica común en la desinfección del agua y mal realizada muchas veces.
Un problema ambiental asociado con su uso es la formación de cloratos como subproductos tóxicos no deseados que pueden afectar a la salud humana y al ambiente si no se gestionan adecuadamente
Desgraciadamente, a partir de los hipocloritos se pueden formar otros residuos tóxicos, incluso más peligrosos
Optimizar las condiciones de almacenamiento: Mantener hipocloritos en envases oscuros y a bajas temperaturas reduce su degradación.
Uso inmediato tras su producción: Disminuir el tiempo de almacenamiento para evitar la formación de subproductos.
Desgraciadamente el producto que se utiliza en las granjas suele llevar mucho tiempo almacenado.
Descomposición química: Los hipocloritos (como el hipoclorito de sodio, NaClO) pueden degradarse con el tiempo o bajo ciertas condiciones (temperatura alta, luz, pH elevado) y formar cloratos (ClO₃).

Reacciones en soluciones acuosas: Durante su almacenamiento o uso en agua potable, los hipocloritos pueden oxidarse y generar cloratos como subproductos.
Procesos industriales: En la fabricación y aplicación de hipocloritos en tratamientos de aguas o desinfección, pueden ocurrir reacciones no controladas que favorecen la formación de cloratos y otros residuos tóxicos.

Control del pH: Mantener valores adecuados para evitar la conversión de hipoclorito en clorato
Métodos alternativos de desinfección:
Explorar opciones como la producción in situ de ácido hipocloroso por electrólisis en las propias granjas.
Afortunadamente, hace unos años se dio en la tecla para producir ÁCIDO HIPOCLOROSO por electrolisis a partir de agua y sal común, sin producir ningún producto residual tóxico como son los cloratos



A sus ventajas como consecuencia de su amplia acción bactericida, virucida, fungicida, esporicida y eliminador de biofilms en las tuberías de agua se da la de su efectividad, potencia y capacidad para ser utilizado como desinfectante natural.
Para darnos cuenta de su actividad, hay que recordar que el ÁCIDO
HIPOCLOROSO es 90 veces más eficiente eliminando microorganismos que el hipoclorito sódico y 10 veces más eficiente que el dióxido de cloro. Siendo capaz de mantener un ORP por encima de los 650 mV en todas las tuberías de la explotación.

Estas propiedades del ÁCIDO
HIPOCLOROSO no alcanzadas por el resto de los biocidas usuales autorizados para la desinfección del agua de bebida de los humanos y de los animales
están haciendo que su incorporación
Es un deber y una obligación como sanitarios garantizar que la potabilización del agua de bebida no contenga residuos tóxicos que puedan perjudicar la salud.
Hoy en día se tienen conocimientos científicos suficientes para rechazar el uso de ciertos biocidas que pueden producir estos residuos tóxicos para la salud y usar biocidas naturales sin peligro.

Y no vale la excusa de que son un poco más baratos y por eso se usan.
Alerta en seguridad alimentaria:
La presencia de cloratos
DESCÁRGALO EN PDF
Michael Czarick; Extension Engineer
Departament of Poultry Science - University Georgia
Traductor: Serafín García Freire
Aunque no lo parezca, un panel evaporativo de 0,30 metros de longitud por 1,5 metros de alto y 15 cm de grosor, tiene una superficie de más de 27,9 metros cuadrados.
Como resultado, una nave con los dos laterales de paneles evaporativos de 21,3 metros x 1,5 metros, tiene más de 3.902 metros cuadrados de superficie de panel donde el agua se evapora, enfriando el aire entrante.


Cuando miramos un panel lateral de 21,3 metros x 1,5 metros, sólo podemos ver los 32,5 metros cuadrados de superficie, no los más de 1.951 metros cuadrados (60 veces más) de superficie interior del panel.
Es importante darse cuenta de que el agua que circula sobre la superficie exterior del panel lo que enfría el aire entrante, sino el agua que se evapora en la inmensa superficie interior del panel donde se produce la mayor parte del enfriamiento.

1,5 metros de alto y 15 cm de grosor pesa aproximadamente 1,1 kg.

El problema es que el panel evaporativo, a menudo se maneja mirando la superficie exterior del panel, en lugar de las superficies interiores.
La superficie exterior del panel evaporativo puede estar seca, pero el interior puede permanecer húmedo y continuar enfriando el aire entrante durante un tiempo sorprendentemente largo.
37,8 36,7 35,6 34,4
33,3
32,2 31,1
30,0 28,9 27,8 26,7
25,6 24,4 23,3 22,2
Una vez empapado de agua, este peso puede aumentar a 3,4 kg o más. Esto significa que, una nave con dos laterales de panel evaporativo de 22,8 metros de largo, contendría más de 340,7 litros de agua, lo que teóricamente podría reducir la temperatura del aire entrante en un día de 32,2 °C (con 50 % de humedad relativa) a 26,1 °C durante casi 15 minutos sin necesidad de añadir agua.
Bomba de agua encendida
Gráfica 1. Rendimiento del sistema de enfriamiento evaporativo en una tarde muy calurosa y seca (HR=35%) - https://youtu.be/ne21iUN6ALw Temperatura
Bomba de agua 2 minutos on/8 minutos off
12:00PM 12:05PM 12:10PM 12:15PM 12:20PM 12:25PM 12:30PM 12:35PM 12:40PM 12:45PM 12:50PM 12:55PM 1:00PM 1:05PM 1:10PM 1:15PM 1:20PM 1:25PM 1:30PM 1:35PM 1:40PM 1:45PM 1:50PM 1:55PM 2:05PM 2:00PM 2:10PM 2:15PM 2:20PM 2:25PM 2:30PM 2:35PM 2:40PM 2:45PM 2:50PM 2:55PM 3:05PM 3:00PM 3:10PM
Temperatura del aire después del panel evaporativo Temperatura de la super cie del panel evaporativo Temperatura aire exterior Enfriamiento

10m 12,5m 14m
Medidas estándar
de10m. 12,5m. 14m.de ancho
Ventilación y aislamiento excepcional
Proyectos llave en mano
Las más de 550 naves de experiencia nos avalan

Cobertizos
Ganaderos
Cosma
almacenamiento, refugio, ganado, etc.


Polg. Ampliación Comarca I
Sin necesidad de proyecto
Calle M, nº6 - 31160 ORCOYEN (Navarra) Tel 948 317 477 Fax 948 318 078 cosma@cosma.es www.cosma.es
En realidad, la temperatura del aire entrante va aumentando con el tiempo a medida que los paneles se secan, pero lo cierto es que, gracias a la alta capacidad de retención de agua de los paneles de celulosa, un panel húmedo continúa enfriando y humidificando el aire entrante mucho después de que se apague la bomba de circulación de agua y se seque la superficie.
De hecho, si bien el borde delantero del panel puede comenzar a secarse a los pocos minutos de apagar la bomba, el interior del panel suele permanecer completamente húmedo durante diez minutos o más, y consecuentemente, la temperatura y la humedad relativa del aire entrante se mantienen prácticamente iguales durante diez minutos o más (Gráficas 1 y 2).
La alta capacidad de retención de agua de los paneles de celulosa se demuestra aún más por el hecho de que, durante el día, pueden tardar 30 minutos o más en secarse por completo (Figura 3).
Por la noche, cuando el aire es más fresco y húmedo, el panel evaporativo puede tardar horas en secarse por completo después de apagar las bombas.
Otra consecuencia interesante de la alta capacidad de retención de agua de los paneles de celulosa, es que, el funcionamiento de una bomba de circulación con temporización de los intervalos de funcionamiento y apagado, suele tener un efecto mínimo en la temperatura y la humedad relativa del aire entrante.
La bomba de circulación de un sistema de paneles evaporativos puede bombear entre 1,9 y 3,8 litros por minuto por cada 30 cm lineales de panel, lo que equivale aproximadamente a diez veces el caudal normal de evaporación de agua de un panel.
Como resultado, la bomba de circulación normalmente es capaz de saturar de agua los paneles en un par de minutos tras su encendido.
Dado que un panel saturado suele causar prácticamente el mismo nivel de enfriamiento durante diez minutos o más, apagar la bomba durante seis, siete u ocho minutos suele producir muy pocos cambios en la temperatura o la humedad relativa del aire entrante.
Si bien el borde delantero puede empezar a secarse después de apagar la bomba durante unos minutos (Gráfica 4), dado que el interior del panel permanece húmedo, tanto el enfriamiento como la humedad producida por el panel tenderán a verse mínimamente afectados durante el tiempo que la bomba está apagada (Gráfica 1).
Esto no significa que el enfriamiento producido por un panel no pueda limitarse programando la bomba con un temporizador de intervalos.
Si se programa una bomba para que funcione menos de un minuto y el clima exterior es suficientemente cálido y seco, el enfriamiento y la humedad producidos por el panel se reducirán.
Es muy difícil estimar cuánto, ya que la cantidad de agua que se evapora cambia constantemente a medida que la temperatura y la humedad exteriores varían a lo largo del día.
¿QUIERES SABER MÁS?
Gráfica 2. Rendimiento del sistema de enfriamiento evaporativo en una tarde calurosa y húmeda (HR=55%) Temperatura ºC
Bomba agua ON Bomba agua OFF
Temperatura del aire después del panel evaporativo
Humedad relativa del aire después del panel evaporativo
Temperatura de la super cie del panel evaporativo
Temperatura aire exterior
Gráfica 3. Rendimiento del sistema de enfriamiento evaporativo en una tarde calurosa y seca (HR=35%)
La Gráfica 1 ilustra la temperatura del aire entrante, así como la temperatura de la superficie del panel en una tarde en la que la temperatura exterior se acercaba a los 37,8 °C y la HR era de aproximadamente el 35 %.
En el día “más fresco”, hubo un secado mínimo de la superficie del panel durante los ocho minutos en que la bomba de circulación estuvo apagada.
Y no hubo diferencia en la temperatura del aire entrante, ya sea que la bomba funcionara de forma continua o con un temporizador de intervalos.
Incluso en un día muy caluroso y seco, aunque la superficie del panel estaba seca aproximadamente cinco minutos después de que se apagara la bomba, el enfriamiento producido por el panel se vio mínimamente afectado, medio grado o menos, durante los ocho minutos en que la bomba estuvo apagada.

La Gráfica 2 ilustra las mismas variables para la misma nave unos días después, cuando la temperatura exterior rondaba los 31 °C y la HR era mucho más alta, del 55 %.
En ambos casos, ya sea que la bomba funcionara de forma continua o temporizada, el enfriamiento producido por los paneles (y, por lo tanto, la humedad producida por el sistema de paneles) fue muy similar.
Temperatura de la superficie del panel evaporativo de 35.3 ºC 11:45 PM (gráfica 1)

Temperatura aire exterior 36,7 ºC

Temperatura del aire después del panel evaporativo 28,3 ºC
Gráfica 4. Temperaturas de la superficie del panel seis minutos después de apagar la bomba en una tarde muy calurosa y seca (36,7 °C / 35 % de humedad relativa).









ESPESORES : 10cm y 15 cm
ALTURAS: 100cm , 150cm , 180cm y 200cm





GRAN VARIEDAD EN CUADROS DE REFR IG ERACIÓN PAR A TRABAJAR POR DEPRESIÓN O POR SOBREPRESIÓN

INFORMACIÓN: OFICINAS: 938 29 04


A veces se piensa que la temporización de la bomba aumenta el enfriamiento con menos humidificación del aire entrante y/o hace que sea más fácil para los ventiladores introducir aire en la nave a través de los paneles porque hay menos agua fluyendo sobre la superficie del panel.
La verdad es que, si un panel está relativamente limpio, el agua que fluye sobre su superficie tiene un efecto mínimo en la depresión de la nave (1,25 pascales) y, por lo tanto, un efecto mínimo en el caudal de aire de la nave.
Además, tanto si fluye mucha agua sobre la superficie de un panel como si la bomba está apagada y no fluye agua sobre el panel, la cantidad de enfriamiento producida por los paneles es esencialmente la misma, ya que, nuevamente, la mayor parte del enfriamiento se produce dentro del panel y no en su superficie exterior (Gráfica 2).
Nota del traductor:
El autor nos comparte en este artículo sus investigaciones sobre la eficiencia de los paneles evaporativos de celulosa. Cabe señalar que actualmente, existe en el mercado otra opción de paneles evaporativos: los paneles evaporativos de plástico, los cuales tienen ventajas sobre los paneles evaporativos de celulosa, que los hacen más recomendables en determinadas circunstancias/necesidades (aguas duras, mayor durabilidad, facilidad para la desinfección, menor obstrucción al paso del aire).
Dado que el enfriamiento por evaporación del aire entrante y la humidificación del aire entrante van de la mano, si el enfriamiento no varía, la humidificación del aire entrante es la misma.
¿Se pueden usar temporizadores de intervalos para controlar el funcionamiento de las bombas de los sistemas de enfriamiento por evaporación?
Por supuesto. Pero lo cierto es que, debido a la capacidad de un panel para retener una cantidad considerable de agua y a su gran superficie interior, esto suele tener un efecto mucho menor en el enfriamiento y la humidificación del aire entrante.
Temporización de los paneles de enfriamiento evaporativo DESCÁRGALO EN PDF

Con respecto a la capacidad de enfriamiento, es similar en ambos paneles (plástico y celulosa), siempre que tengamos en cuenta ciertas diferencias en la instalación de los paneles evaporativos de plástico (menor velocidad máxima, mayor caudal de recirculación y agujeros de salida de agua más próximos).

Para saber más sobre las diferencias entre ambos paneles evaporativos, es recomendable leer los artículos:
aviNews Junio 2023: Cinco diferencias significativas entre los paneles evaporativos de plástico y de cartón.
aviNews Agosto 2022: Refrigeración por paneles de plástico vs paneles de cartón.
Eduardo Cervantes López Consultoría Internacional - Gerencia Productiva e Innovadora en Procesamiento de Aves

Actualmente existen miles de millones de personas que no pueden satisfacer sus necesidades básicas en distintas regiones de la tierra.
Desde hace décadas, varias corporaciones que han creado un entorno mágico han decidido afrontar este “reto”. Para tal efecto, sus integrantes conforman una sólida unidad monolítica que les permite encontrar soluciones efectivas que no afecten el ecosistema, haciéndolas sostenibles en el tiempo.



Lograr estos objetivos monumentales ha demandado replantear los pilares estructurales de las empresas tradicionales:
Propósito: ¿Qué quieren cambiar en el mundo?
Misión: ¿Cuál es la estrategia que llevarán a cabo para alcanzarlo?
MISIÓN: consideran a sus colaboradores como “fuentes” y no recursos como tradicionalmente se han denominado.
Una “fuente” es como el “sol”, prácticamente inagotable, generando luz y calor permanentemente.

Visión: ¿Cómo se imaginan que será el mundo cuando el propósito se haya conseguido ampliamente?
PROPÓSITO: se presentan algunos ejemplos:
Disney: Utilizar la imaginación para hacer feliz a millones de personas
Southwest Airlines: Darle a la gente la libertad de volar
Johnson & Johnson: Aliviar el dolor y el sufrimiento
Este enfoque tan puntual demanda que los procesos de selección y contratación del personal sean muy minuciosos y rigurosos, porque deben escudriñar que los valores y cultura de los candidatos coincidan con el propósito de las compañías.

La gente que contratan recibe entrenamientos sistemáticos para que lideren con la mayor eficiencia las actividades asignadas dentro de un ambiente creativo sin límites, recordando en todo momento que se debe contribuir a mantener y restablecer las condiciones básicas en un mundo que ha sido lamentablemente azotado en cada uno de sus pilares estructurales: fuentes hídricas., flora, fauna, polos, aire, etc.
En concordancia con el concepto de “fuente”, estas organizaciones consideran prioritario fomentar y conservar un adecuado y razonable estado de plenitud en sus colaboradores.
Esta decisión encaja en el rumbo de inversiones de largo plazo, que gradualmente disminuyen el problema de rotación de los resultados económicos y sociales –productos y servicios– de las empresas. Fomentan el trabajo en equipo.
VISIÓN: Acabar con la hambruna y deplorable calidad de vida que han padecido las civilizaciones desde hace muchos años.
Por tal motivo, se debe reducir al mínimo posible los desechos y los gastos de operación de sus procesos para permitir que sus productos y servicios puedan usarlos y disfrutarlos todos los niveles económicos de la sociedad.
Los colaboradores al conservarse bien respaldados en estos temas neurálgicos que inciden en la creatividad y la innovación estarán “encantados” - nivel superior a la tradicional respuesta: me gusta el trabajo que realizo.


En consecuencia, superaran las expectativas de los directivos de las organizaciones y de los clientes que adquieren y usan sus productos y servicios.
Estas condiciones de los consumidores se manifestarán masivamente personalizadas y mediante las redes sociales.
Cada área de la compañía se considera una unidad productiva, que debe responder por el cumplimiento de los índices de gestión en cuanto a calidad de producto y/o servicio y gastos de operación.
Ejemplo: en Whole Food Market, que tiene muchas tiendas en distintas ciudades de USA, los resultados de cada sección se comparan con los de las distintas tiendas, a fin de establecer cuáles son los mejores y presentar la configuración ideal de las secciones del supermercado objetivo a lograr.

Estas remuneraciones especiales se entregan a los equipos y no a los individuos que los conforman La filosofía de los equipos de trabajo se fundamenta en el hecho de la sensación de pertenencia y seguridad que producen.
Hay que recordar que la seguridad se traduce en tranquilidad y a su vez en felicidad, definida esta como el disfrutar de todo lo que lo rodea.
Por ello no existe egoísmo y las ideas saltan de una persona a otra, mejorándose de esta manera hasta quedar definida cabalmente.
Se ha definido claramente que todos sus empleados deben encontrarse en un estado integral físico y psicológico paradisíaco. Profesan la filosofía que personas sanas tienen un rendimiento en constante crecimiento.
El equipo de colaboradores favorece que las ideas evolucionen y maduren. Lo antes expuesto se enmarca en el concepto de la ¡Motivación intrínseca!.
Adicionalmente, se reconoce la “antigüedad” como un factor inequívoco de compromiso con el propósito de las empresas conscientes.
Este plus es valorado independientemente acorde con el número de años laborados.
En consecuencia, monitorean puntual y personalizadamente a aquellas personas que presentan entre otros los siguientes problemas de salud:
Niveles de colesterol
Índice de masa corporal
Relación peso – estatura
Presión arterial
Está prohibido fumar dentro y fuera de la empresa

Para lograr un equipo saludable permanente se tiene un programa de incentivos en especie.
Toda persona que haya sido rescatada de este océano de alto riesgo con desenlaces a veces fatales, reciben un reconocimiento público en la empresa y portan una identificación, estrategia tendiente a que las personas asuman el compromiso por convicción de estar 100% saludables.

Sistema MOTOCULTOR


Máquinas avícolas complementarias - CMC

BARREDORA
Enganche a tractor
Jaulas de transporte de 97x58 cms. + 21% de espacio de carga (Jaula Multi 100)

EXTENDEDORA DE PAJA
Enganche a tractor

EXTENDEDORA DE VIRUTAS
Enganche a tractor

Jaulas de transporte de 108x58 cms. + 35% de espacio de carga (Jaula Multi 110)




Disponible también en 97 cm. largo para pequeños camiones.
Medidas en cms.: 108x58x27 (pollos) 108x58x21 (pesos)
Fácil ensamblaje en destino. Con fondo perforado o sólido (plegables).

Cestas “Multi Open Top 100 y 110” abiertas por arriba y sin tapa Sin puerta lateral


Detergente 20kg

A continuación, se presentan algunas estrategias aplicables al negocio avícola –huevos y pollos-, centrando la atención en este último.
Un personal “elite” actualizado conceptual y operacionalmente, identificado y consolidado con el propósito, hace posible su cumplimiento.
Alimentar al mundo con los mayores porcentajes de proteína de origen animal: carne de pollo: 21% y huevo: 31%, cumpliendo estrictamente todos los protocolos de bioseguridad, bienestar animal, grupo humano saludable y trazabilidad en cada etapa de la cadena productiva, garantizando su incomodidad.
Prefaena
Objetivo: reducir decomisos de pollos ahogados (DOA) y pérdidas de pollo vivo.
Actividades para evaluar:
Cuadrillas de captura
Cerramientos
Recolección y enjaulado
Cargue de camiones.
Garantizar que nuestros productos sean un pilar indispensable para mantener una nutrición balanceada con el fin de asegurar el desarrollo de la población a lo largo del tiempo. Así mismo, sus desechos serán reutilizados y/o procesados para no afectar al ecosistema del planeta tierra.

Conductores de camiones:
Hematomas en las alas, al no bajar la velocidad en las curvas
Hematomas en las pechugas
Objetivo: disminuir pollos ahogados (DOA)
Naves de espera
Muelles de recibo y colgado

Secciones: colgado hasta desplumado
Objetivo: cumplimiento o reducción de parámetros de proceso
Pollos mal sangrados
Sobre – escaldados
Última desplumadora
Vasos sanguíneos ensanchados - alas
Alas dislocadas: sin sangre y con sangre
Daños en la piel: pechuga y muslos
Pollos destrozados
Cero plumas
Se observa sangre en el piso trayecto hasta transferencia a evisceración. Fotografía 1.
Retiro de cabezas – a ras del cervical atlas.
Corte de patas – un centímetro sobre la articulación con el muslo.

Fotografía 2. Proceso de eviscerado.
Sección: Evisceración
Corte de cloaca - ¿Hay presencia de materia fecal?

Corte de abdomen: longitud adecuada para no cortar los perniles – parte inferior del muslo – evitando el descaderamiento.
Evisceración - retiro de la grasa abdominal - %? Separación vísceras no aptas para consumo humano.
Retiro de hígado, corazón, vesícula biliar – pollos manchados con hiel.
Retiro: mollejas, limpieza y remoción cutícula. Pérdida de rendimiento en carne %?
Salida lavadora – presencia de heces, residuos de sangre, restos de epidermis, drenaje total agua almacenada en la cavidad abdominal, presencia de órganos. Fotografía 2.

Fotografía 1. Salida de la desplumadora.

Sección: Enfriamiento
Con agua - % de absorción:
Pre – enfriamiento.
Enfriamiento –salida del equipo: temperatura medida en la pechuga, inferior a 3°C, aspecto de la piel impecable y húmeda. Fotografía 3.
Con aire
Aspecto de la piel limpia y húmeda, temperatura: menor o igual a 4ºC.
Escurrimiento y empaque pollo entero.
Tiempo promedio de escurrimiento y descolgado por pesos: 2 minutos
Pérdida de hidratación: 2%.
Área climatizada: 10ºC a 15ºC.
Temperatura promedio carcasas: menor o igual a 3ºC.

Evitar formación cuellos de botella
Aumenta la pérdida de hidratación.
Incremento temperatura promedio de los pollos procesados.
La temperatura de los pollos embolsados y encestado en cajas plásticas y/o de cartón no debe superar los 4ºC, al momento de ingresar a las camas frigoríficas.
Resumiendo, las “compañías conscientes” definen prioritariamente el propósito, misión y visión, centrando la atención en el bienestar y salud de todas las personas que trabajan en ellas, quienes por convicción están identificadas con el propósito, asegurándose siempre que su operación no afecte integralmente al ecosistema de este planeta.
Esta filosofía empresarial amigable con el medio ambiente es aplaudida por las comunidades que compran sus productos y/o servicios, los cuales las comunican a través de las redes sociales con efectos virales.

Empresas Conscientes: Estrategias Gerenciales para aumentar la productividad, mejorando el bienestar del personal que labora en la prefaena y el procesamiento DESCÁRGALO EN PDF


Leonardo Ortiz Escoto Gerente general Improasa
La producción de pollo a nivel mundial crece de forma permanente año a año. Prueba de ello es que entre el 2010 y el 2023 , la producción de pollo ha aumentado un 29.4%.
Todo esto refleja las grandes oportunidades de tener materia prima disponible, brindar valores agregados y diferenciarse de la competencia.
En el caso de España, el consumo de pollo aumentó en un 16% el año 2023 con respecto al 2022, lo que también significa un incremento importante.



El hecho de contar con suficiente materia prima para desarrollar estos valores agregados y tener un amplio mercado hace que desarrollar pollos condimentados listos para cocinar sea una excelente opción para las industrias del embutido, pero también para las avícolas que faenan pollo, de elaborar estos productos y de esta forma mejorar la rentabilidad y competitividad.
La materia prima principal es el pollo entero, fresco refrigerado.
El congelamiento lento provoca que los cristales de agua formados en la carne sean grandes y muchos de estos cristales se formen fuera de las fibras y en el tejido conectivo, trayendo consigo altas mermas y desnaturalización de las proteínas una vez la carne ha sido descongelada.

Si ha estado congelado, debe pasar por un proceso adecuado de descongelación que en el proceso nunca supere los 3°C para evitar proliferación microbiológica.
La calidad de la carne descongelada va a depender del proceso de congelación, del mantenimiento y del proceso de descongelación. Es importante conocer los efectos de la congelación y los tipos de congelación en la calidad de la carne.

Por ello, se recomienda una congelación rápida con formación de cristales pequeños. De esta forma, se preserva mejor el color y la capacidad de retención del agua, además de menor merma por descongelación y menor posibilidad de ataque de microorganismos.

El proceso de descongelación en general es un proceso más lento que el de la congelación, debido a que la conductividad térmica es menor en la carne congelada que en la carne no congelada.
El propósito de la descongelación es poner a los productos lo más cercano posible a como se presentaba el producto antes de descongelar.
El proceso de descongelación es el proceso inverso de la congelación donde el punto más frío esta vez es el punto más interno del corte de carne con o sin hueso, el cual debe garantizar la descongelación total.
max 4ºC
Los métodos de descongelación deben garantizar la inocuidad de la carne como requisito esencial evitando que en este proceso alguna parte de la carne quede expuesta por encima de 4º Celsius donde habría un crecimiento bacteriológico con su consecuente deterioro.
Tenemos que aportar energía a una masa de carne para aumentar su temperatura lo más rápido posible, normalmente desde -18°C hasta 0°C. Pero tenemos limitaciones importantes:
No alterar o perder proteínas, ya que perderíamos la función tecnológica de la carne.
Controlar y reducir las condiciones de riesgo que favorezcan crecimientos microbianos.
No demorar el proceso, que puede generar desnaturalización de las proteínas, oxidación de los lípidos y un efecto negativo en las características organolépticas de la carne.
Evitar la pérdida de agua, con la consiguiente merma económica .

Existen varios mecanismos tradicionales de descongelación y también se han desarrollado equipos de descongelación con el propósito de obtener los mejores resultados en calidad, reduciendo


Los programas de rotación eficaces requieren coccidiostatos de confianza. Nuestras soluciones recién adquiridas:
(lasalocid, ionóforo divalente)
(robenidina, químico) (decoquinato, químico) (ionóforo glicósido)
Te ofrecen la flexibilidad y la confianza necesarias para combatir la coccidiosis y optimizar el rendimiento de tu explotación.
¡Consúltanos para definir la mejor estrategia para tu granja!
Conozca más sobre nuestros productos

Para efecto de difundir la condimentación de forma homogénea en toda la carne de pollo, se utiliza una salmuera para inyección en una inyectora de agujas perforadas.
Las cuales conducen la salmuera producto de una bomba de presión que contiene la inyectadora la cual es impulsada con diferentes niveles de fuerza según la presión que se programa en el display táctil.
Las inyectoras pueden ser de varios tamaños que se ajustan a cada necesidad de proceso y de producción. Se fabrican máquinas inyectoras con algunas decenas de agujas hasta centenares de agujas para alta producción de pollo condimentado.
También hay opción de adquirir inyectoras de baja presión o alta presión, cada una con sus ventajas, adecuándose al proceso de cada empresa avícola y a los niveles de inyección que se requieren.
Además de la presión también se programa la velocidad de la banda y esta programación hará que haya mayor o menor cantidad de salmuera agregada al pollo lo que en términos simplificados se le denomina porcentaje de inyección o nivel de inyección.
La posición del pollo debe ser pechuga arriba para que la aguja penetre en el área donde hay mayor cantidad de carne del pollo.
Para la preparación de la salmuera, es importante considerar sus componentes, los cuales dependerán de los atributos que el cliente busca en el pollo y de los sabores a los que el consumidor está acostumbrado.

En la salmuera se incorporan ingredientes que participan en procesos bioquímicos con la carne de pollo para otorgar atributos organolépticos deseables, mejorar su jugosidad y aumentar su valor de mercado.
El uso de la mayoría de estos aditivos está regulado por el Codex y por instituciones regulatorias de cada país o región para evitar que un exceso pueda perjudicar la salud del consumidor. Se cataloga como aditivo todo aquel producto que se incorpora en una formulación cárnica con una función específica aportando características organolépticas intrínsecas al producto y/o colaborando con la disponibilidad del mismo a través de la prolongación de su vida útil.
Los aditivos generalmente se usan en pequeñas cantidades exceptuando los clasificados GRAS.
Los aditivos no se consumen por sí solos.
Deben cumplir con requisitos de pureza y de elaboración con normativas BPM.
Entre los ingredientes más utilizados en la salmuera se encuentran:
Fosfatos, que ayudan a mejorar la retención de agua.
Proteínas solubles, de origen vegetal, animal o ambas.
Pequeñas cantidades de carragenina, utilizada para mejorar la textura.
Sal, un componente esencial en la formulación.
Realzadores de sabor, que potencian el perfil gustativo del producto.
Condimentos, los cuales deben cumplir con el requisito esencial de ser solubles y disolverse completamente en el agua, al igual que los demás ingredientes.

Para efectos de tener una barrera adicional en la vida útil del pollo fresco condimentado se puede hacer uso de lactato de sodio en 2 a 3% el cual es un bacteriostático muy eficaz y ampliamente usado en la industria avícola.
Recuerde que las concentraciones adecuadas de sal, fosfatos, y demás ingredientes deben ser calculados con respecto al producto final.






La sal o cloruro de sodio puede ser de origen marina o de mina. Es considerada un elemento fundamental de todo alimento ya que provee sabor.
En el caso de los embutidos también tiene una función muy importante para solubilizar las proteínas miofibrilares y acentuar la capacidad de retención de agua.
Un rango habitual de concentración de sal oscila entre 1.6 a 1.8% aunque en algunas regiones o países se consume pollo con un perfil de sal superior al 1.8%.

La concentración de sal indicada se debe calcular para producto final, es decir que la concentración de sal en la salmuera debe ser superior a 1.8% para que al final podamos obtener la cantidad de sal esperada.
Fosfatos de sodio: El más usado es el tripolifosfato de sodio, pero también se usan difosfatos y hexametafosfatos o mezclas entre estos.
Está considerado como un emulsificante. Se usa en un rango de 0.3 a 0.5% y se obtiene a través de un proceso químico de rocas marinas, alcanzando una pureza superior al 95% . Para su uso, es fundamental garantizar que sea de calidad Food Grade.

Uno de los parámetros clave a considerar es su contenido de arsénico, fluoruros y metales pesados. Su función principal es mejorar la retención de agua en las proteínas miofibrilares, optimizando al máximo su funcionalidad.
Además, el fosfato contribuye a estabilizar el pH del pollo.
Ertirobato de sodio E316: Su origen es la remolacha o de la caña de azúcar. Es el antioxidante más usado para evitar la oxidación de la mioglobina que contiene hierro.
La cual si no es tratada de forma adecuada en presencia de oxígeno y calor se oxida y produce un color verdoso, después marrón y posteriormente oscuro. Se usa un máximo de 0.1%.
Como antioxidante, se emplea ácido ascórbico, el cual puede añadirse en una
Nota: Para efecto de incluir un ingrediente el productor debe consultar la norma particular del país o región.

Cuanto más se acerque la salmuera a 0°C, mejores serán los resultados.

Una vez que el pollo ha sido inyectado, es fundamental realizar su pesaje para calcular el porcentaje de inyección, el cual debe coincidir con el porcentaje utilizado en la formulación de los ingredientes.

esté completamente libre de grumos y se mantenga por debajo de 4°C para preservar la cadena de frío. Esto favorecerá una mayor retención, resultado de varios factores en el proceso de inyección, como:
Uso de ingredientes adecuados proporciones correctas.
Ejecución precisa de la inyección, considerando la eficiencia de la máquina inyectora.
Control de temperatura tanto de la salmuera como del almacenamiento en frío.
Elaboración de pollo entero condimentado DESCÁRGALO EN PDF
Una diferencia significativa entre ambos valores podría afectar el sabor y aroma del pollo condimentado.
Tras la inyección, el pollo se empaca, preferiblemente en bolsas al vacío, y se envía a cuartos fríos, asegurando que permanezca dentro de la cadena de frío durante la distribución y la expedición final
Este recorrido por los procesos y oportunidades de un producto en constante crecimiento en el mercado busca aportar valor e interés a los lectores, especialmente a aquellos que aún no han incorporado valores agregados a su producción de pollo de engorde.
Este podría ser el primer paso para desarrollar productos con mayor valor comercial, generando mayores utilidades y fortaleciendo la marca.


Eric L. Jensen1 y Dra. Carolyn L. Miller
1DVM, MAM, diplomado de la ACPV, 2DVM, MAM, diplomada de la ACPV (2001).
Revisado por Jose J. Bruzual DVM, MAM, MSc, diplomado del APCV, PAS Contenido de Aviagen
La infección por o estafilococosis se refiere a las enfermedades causadas por las bacterias del género Staphylococcus distintas lesiones según la zona afectada (Tabla 1).
Staphylococcus aureus (S. aureus) es una bacteria en forma de coco grampositiva y catalasa-positiva que forma grupos similares a racimos de uvas en frotis coloreados.


En la población de reproductoras, el S. aureus es la forma más común de la infección y causa tenosinovitis (inflamación de la vaina del tendón) y artritis en las articulaciones del corvejón y la rodilla (pierna) en aves de todas las edades.
Tabla 1. Infecciones estafilocócicas en las aves de corral.
UBICACIÓN
Hueso

Articulación
Saco vitelino
Sangre (septicemia)
Piel
Patas
EDAD LESIÓN RESULTADO
Cualquiera, en general, mayores
Cualquiera, en general, mayores
Pollitos
Cualquiera
Jóvenes
Adultos
Osteomielitis Cojera
Artritis/sinovitis Cojera
Onfalitis Muerte
Necrosis generalizada Muerte
Dermatitis gangrenosa Muerte

Absceso plantar (pododermatitis) Cojera
Fuente: Claire B. Andreasen. Staphylococcosis. En: Diseases of Poultry. Decimocuarta edición. Ed. 2020.
Las infecciones por Staphylococcus se producen con más frecuencia en condiciones que generan cortes en el recubrimiento epitelial, la mucosa intestinal o la barrera de la piel, y puede verse exacerbada por enfermedades inmunosupresoras o situaciones que les permitan generar una enfermedad. Por eso, se la considera una bacteria oportunista.
Los momentos de significancia clínica en la vida de las aves se resumen en cuatro períodos:
La onfalitis y necrosis de la cabeza femoral (NCF), o la condronecrosis bacteriana con osteomielitis (CBO) suelen relacionarse con la contaminación del huevo o de la planta de incubación, y con procedimientos como los tratamientos en las falanges.
Las lesiones de los tarsos rojos podrían permitir que los patógenos ingresen por la barrera de la piel. Estas situaciones son más comunes durante los meses cálidos y húmedos del año.
Articulaciones del corvejón y la rodilla infectadas en forma secundaria debido a coccidiosis o reacciones graves a las vacunas (Figura 1).


Figura 1. Tarsos inflamados por una infección de Staphylococcus.
Articulaciones del corvejón y la rodilla infectadas en forma secundaria por problemas con la vacunación o por una manipulación inapropiada durante la vacunación.
La muy alta densidad, la mala distribución del alimento y el espacio insuficiente en los comederos empeoran estos problemas.
Articulaciones del corvejón y la rodilla infectadas, y pododermatitis (absceso plantar) causados por los problemas con el movimiento, el apareamiento y el comienzo de la producción de huevos.
La agresión de los machos, las lesiones asociadas con el mal mantenimiento de los equipos de alimentación, las cajas de nidos y los slats (rejillas), y la mala calidad de la cama también

El Staphylococcus aureus es un organismo extendido en el entorno de las naves de reproductoras y puede aislarse en las camas, el polvo y las plumas.
La bacteria se considera un residente normal de los pollos —se alojan en la piel y en las plumas, y en las vías respiratorias e intestinales— y, en condiciones normales, no supone una amenaza.
El organismo debe ingresar al sistema circulatorio para causar enfermedades. Por lo tanto, la probabilidad de infección aumenta con una lesión, que les brinda a las bacterias una ruta de ingreso.
Las dos rutas de infección más obvias son a través de cortes en la piel o en la mucosa intestinal, posiblemente como resultado de una herida causada por una lesión o un problema intestinal, como la enteritis o la coccidiosis.


Además, en algunos estudios se observó que otra ruta de ingreso Staphylococcus vías respiratorias. La mala calidad de aire o las vacunas respiratorias más virulentas facilitan el ingreso de los estafilococos por
Una vez que están en circulación, los estafilococos tienen una alta afinidad por las superficies ricas en colágeno, como la superficie de las articulaciones y las vainas sinoviales que rodean las articulaciones y los tendones.
Los estafilococos también se ubican en los cartílagos de crecimiento de los huesos con crecimiento activo —lo que explica la mayor incidencia de la necrosis de la cabeza femoral— también llamada condronecrosis bacteriana con osteomielitis (más prevalente en los pollos jóvenes en relación con los más adultos).
El mal manejo puede ser una causa significativa de inmunosupresión y debe evitarse, ya que puede afectar la función inmunitaria o crear una situación en la que las aves sean más susceptibles a la infección.

La probabilidad de que los estafilococos puedan causar una enfermedad aumenta cuando el sistema inmunitario del portador se ve afectado.
Se demostró que los agentes virales, como la enfermedad infecciosa de la bursa (IBD) y el virus de la anemia del pollo (CAV), suprimen la función inmunitaria y aumentan la incidencia de dichas enfermedades estafilocócicas, como la CBO y la dermatitis gangrenosa.
Otros agentes que pueden causar efectos inmunosupresores similares incluyen el virus de la enfermedad de Marek, el reovirus y las aflatoxinas en el alimento.
Los factores más importantes que afectan el bienestar del ave incluyen:
Muy alta densidad
Alimento insuficiente
Espacio de bebederos y de nidos
Mala distribución del alimento
Manipulación inapropiada
Limpieza y procedimientos de bioseguridad inadecuados
Temperaturas extremas
Mala ventilación y calidad del aire

Se propuso que la deformidad del esqueleto tiene una función en la artritis estafilocócica.
Las deformidades angulares y rotacionales de las extremidades — como las deformidades de valgus y varus— aumentan la presión sobre las articulaciones y la arquitectura esquelética de apoyo.
El consecuente daño en los tendones, los ligamentos y las superficies articulares brindan a las bacterias la oportunidad de colonización.
La actividad insuficiente durante la crianza también hace que las estructuras esqueléticas sean más susceptibles a lesiones leves, como esguinces y distensiones. Estas lesiones leves pueden ofrecer espacio para una infección.
Las prácticas de manejo conocidas por ayudar a reducir el riesgo de enfermedades incluyen:
Promover el excelente desarrollo temprano y la integridad del tracto intestinal.

En el tracto intestinal, hay una gran comunidad de bacterias conocidas como la microbiota intestinal.
Mantener una integridad óptima de la piel.
Prevenir y controlar los problemas respiratorios y las reacciones respiratorias a las vacunas.
Optimizar el manejo para prevenir o minimizar factores que pueda afectar el bienestar.
El desarrollo temprano del tracto intestinal es importante para la salud entérica a largo plazo y más benéfico para la salud de las piernas, pero, en general, se pasa por alto.
No brindar las condiciones de crianza correcta probablemente cause un desarrollo insuficiente de las vellosidades, lo cual hace que el tracto intestinal tenga una capacidad de absorción reducida.
Un entorno que promueva el desarrollo apropiado de los tejidos intestinales durante la vida joven del ave garantiza una buena barrera intestinal, y esto previene que las bacterias, como el estafilococo, infecten las aves jóvenes.
Estas bacterias son esenciales para promover y mantener la salud entérica. Son miembros habituales de esta comunidad, que pueden causar enfermedades si pasan del tracto intestinal al cuerpo del ave (p. ej.,E. cecorum, E. coli y S. aureus).
Las células que recubren las vellosidades tienen una función secundaria a la absorción de nutrientes: forman una barrera que previene que las bacterias pasen del tracto intestinal a los tejidos intestinales (Figura 2)
Esta barrera puede fallar por una infección, estrés por calor, mala calidad de los ingredientes, desequilibrio en la microbiota intestinal y micotoxinas.
Después de una falla en la barrera, se produce una reducción en la absorción de nutrientes, que puede causar un crecimiento insuficiente en las aves y un excesivo crecimiento bacteriano en el tracto intestinal (disbacteriosis).
Además, las bacterias también pueden ingresar a los tejidos intestinales, donde podrían transportarse por la sangre hacia los huesos y las articulaciones, y causar enfermedades.
Por lo tanto, garantizar un buen manejo, una nutrición óptima y estrategias de control de enfermedades es esencial para mantener la integridad de esta barrera.

Vellosidades bien desarrolladas
Garantizan la absorción óptima de los nutrientes para el sano desarrollo y el crecimiento óseo
Bacterias
Buena barrera intestinal
Vasos sanguíneos
Es importante que las bacterias permanezcan en el tracto intestinal
Vellosidades mal desarrolladas
Reducen la capacidad de absorción que puede afectar la ingesta de nutrientes o impactar negativamente en el desarrollo y el crecimiento óseo
Las bacterias viajan hacia los huesos a través del torrente sanguíneo
Bacterias
Barrera intestinal deteriorada
Vasos sanguíneos
Cuando la barrera está deteriorada, las bacterias pueden entrar en los tejidos intestinales y en el torrente sanguíneo
Figura 2. El rol del desarrollo de las vellosidades para garantizar una buena barrera digestiva.
El control efectivo de la coccidiosis es necesario para minimizar el daño al recubrimiento del intestino.
Si el recubrimiento del intestino está excesivamente dañado, los organismos estafilocócicos pueden ingresar al torrente sanguíneo por los vasos sanguíneos intestinales y causar el desarrollo de estafilococosis secundaria.
Debe manejarse el entorno en la nave de las aves para prevenir rasguños que podrían favorecer el ingreso de las bacterias estafilocócicas por la piel. El manejo de la cantidad y la distribución de la luz, del alimento y del agua es necesario para evitar los rasguños. Las aves deben tener espacio adecuado para el agua y el alimento, que se logra evitando las densidades poblacionales excesivamente altas.
También es necesario algo de ejercicio durante la crianza para fortalecer huesos, articulaciones, músculos y tendones. Esto se puede lograr con una intensidad de luz adecuada y colocando perchas o bebederos sobre slats (rejillas) bajos para motivar la actividad.
Infecciones que destruyen la barrera intestinal (p.ej. coccidiosis)
Factores que afectan la integridad intestinal (p.ej. estrés por calor, alimentación, micotoxinas)
El cuidado en la manipulación de las aves durante la vacunación y la transferencia es esencial. Se debe tener cuidado durante la vacunación para prevenir la contaminación de la vacuna, y las agujas y aplicadores de las membranas de las alas se deben cambiar con frecuencia. Los alimentos potenciados y las vitaminas y complementos pueden ayudar a aliviar el estrés asociado con la manipulación.
Minimice la cantidad de veces que se manipula la parvada combinando tantos procedimientos como sea posible. Atrape las aves con cuidado y sosténgalas de modo que se minimice la angustia, los daños y las lesiones (p. ej., magulladuras o dislocaciones). Asegúrese de que haya dos puntos de contacto en el ave: ambas piernas, las alas o los costados.




Como las heridas brindan una puerta de entrada significativa para los estafilococos, se deben tomar medidas para reducir las chances de lesiones. Los objetos afilados —rocas, cables, metales, bordes afilados de los equipos, uñas y astillas— deben retirarse. Los slats (rejillas) y los equipos deben estar bien mantenidos. Establecer la altura correcta del slat (rejilla) (máximo entre 25 y 30 cm) y usar rampas reduce las lesiones en las piernas y las falanges.
3. Prevención y control de problemas respiratorios.
La prevención de la exposición temprana a los virus inmunosupresores, como los virus de la bursitis infecciosa, de la anemia del pollo y de la enfermedad de Marek, brindando niveles altos de anticuerpos maternos, vacunas y sanitización también previene la estafilococosis.
Las vacunas respiratorias más virulentas — enfermedad de Newcastle, cepa LaSota, por ejemplo— pueden causar reacciones que permiten el ingreso de bacterias.
No se ha probado que las vacunas bacterianas estafilocócicas sean beneficiosas. La interferencia bacteriana usando la cepa 115 del Staphylococcus epidermidis en pavos disminuyó la estafilococosis y mejoró la viabilidad en pavos (Jensen, 1990).
Sin embargo, no se han demostrado beneficios en los estudios en pollos (McNamee y Smyth, 2000). Los productos de exclusión competitiva y los probióticos pueden ayudar a reducir la incidencia de la estafilococosis, pero se justifican más investigaciones.
Mantener una buena calidad de cama reduce el daño al cojinete plantar. La ventilación apropiada, la buena calidad del material de la cama, la remoción de la cama apelmazada y el correcto manejo de los bebederos ayudan a preservar la calidad de la cama.
El surgimiento de la madurez sexual y la producción de huevos puede ser un período estresante. Se debe tener cuidado para lograr la sincronización sexual entre los machos y las hembras, y adoptar las recomendaciones de relaciones de apareamiento y la cantidad de nidos por gallina.
El manejo apropiado del alimento y los programas de iluminación durante este período crítico es esencial.

Una limpieza y desinfección meticulosas entre las parvadas puede minimizar el nivel de problemas con el Staphylococcus.
La mayoría de los desinfectantes de buena calidad son efectivos contra el Staphylococcus
Las observaciones de campo mostraron que la limpieza de la fuente y las líneas de agua puede reducir los problemas en las piernas.
También se ha demostrado que es beneficioso usar un sistema de agua cerrado (bebederos de tetina) y un programa de sanitización del agua.
La enfermedad estafilocócica relacionada con el huevo y la planta de incubación se evidencia en pollitos deprimidos, una mortalidad temprana elevada (primeras 2 semanas), ombligos húmedos o sin sanar, y onfalitis.
Otro factor que predispone a las enfermedades son las abrasiones en la piel (tarsos rojos) durante el nacimiento. También se puede producir una infección en el hueso (osteomielitis),que suele causar la necrosis de la cabeza femoral.

Los pollos con artritis y tenosinovitis evidencian cojera. La articulación del tarso suele estar comprometida, inflamada y caliente al tacto. La articulación de la rodilla es la segunda articulación más afectada. Al abrir la articulación y el tejido circundante, se observa un exudado caseoso de color amarillo o blanco. La inflamación también puede ser evidente en la superficie articular y los tendones cercanos.
Con trabajo experimental, se ha demostrado que la infección temprana con Staphylococcus o reovirus puede causar inflamación en la articulación del tarso y los tendones cercanos (Hill, et al., 1989).
La infección crónica de los tendones con cualquiera de esos organismos causa fibrosis progresiva y calcificación. A medida que las aves aumentan de peso o se los ubica en las naves con slats (rejillas), esos tendones pueden romperse y causar una pérdida permanente del uso de la pierna afectada.
Se puede formar un nudo grande (fibrosis) en el lugar de la ruptura. Se debe pensar en un diagnóstico diferencial para la artritis del reovirus usando una combinación de lo siguiente:
Serología.
Histopatología.
Aislamiento del virus.
Identificación del virus por medio del análisis molecular.
Sin embargo, el diagnóstico se dificulta si han pasado más de 5 semanas desde la infección, porque las lesiones microscópicas importantes se vuelven similares con el paso del tiempo.
A partir de la mayoría de la evidencia de problemas de campo, no se logra probar de forma satisfactoria que los reovirus son la causa, y la mayoría de los tejidos han mejorado o se curaron sin cambios en la situación del reovirus de la parvada.

Inicialmente, el área que rodea el tendón roto — generalmente se observa en el tendón gastrocnemio, por encima del tarso— cambia de color, se vuelve de color rojizo - púrpura por la hemorragia, y luego, pasa a verde (Figura 3)

Figura 3. Tendones rotos: (A) color verdoso, (B) tendón roto (hemorragia), (C) tendón roto expuesto.
Las infecciones estafilocócicas del cojinete plantar y las falanges (pododermatitis) son comunes en los pollos adultos (Figura 4). La inflamación grave del cojinete plantar y las falanges causa la cojera subsiguiente.





La osteomielitis puede causar cojera o parálisis según si se ve afectado un hueso largo o la columna vertebral (Figura 5). Las zonas óseas que suelen verse afectadas son la cabeza proximal del tibiotarso, el fémur proximal (caderas) y las vértebras torácicas libres (T4).

Figura 4. Absceso plantar o pododermatitis.
Figura 5. (A) Osteomielitis en el extremo proximal de la tibia, (B) necrosis en la cabeza femoral leve,(C) necrosis en la cabeza femoral aguda, (D) y (E) Osteoartritis Vertebral (VOA), vértebras torácicas libres.







Las aves con infecciones en los huesos de las piernas se niegan a caminar. Cuando el fémur se ve afectado, la sección proximal del fémur se rompe de la diáfisis cuando se desarticula la cabeza femoral de la articulación de la cadera (necrosis en la cabeza femoral).
Las lesiones macroscópicas pueden incluir exudado amarillo - marrón o necrosis en la cabeza del fémur (metáfisis). Las infecciones en los espacios articulares entre las vértebras pueden causar parálisis en las piernas. Suele necesitarse un examen histológico del tejido fijado con formalina para un diagnóstico preciso.
1. Manejo de los huevos para incubación: higiene del huevo y la granja
Use la temperatura apropiada en la sala de huevos de la granja para evitar la condensación.
Recolecte los huevos con frecuencia y mantenga el nido limpio.
Manipule los huevos siguiendo las prácticas recomendadas de la granja.
Siga pautas de sanitización estrictas.
No envíe huevos del piso a la planta de incubación.

Incube huevos limpios.
Evite la condensación de los huevos.
Use correctamente las lavadoras de bandejas y de las cajas de pollitos.
Use bandejas para huevos, bandejas de incubación y cajas de pollitos limpias.
3. Manejo de la granja: factores que afectan la comodidad y el bienestar de las aves
Brinde el espacio recomendado para los comederos.
Brinde las densidades poblacionales recomendadas.
Distribuya el alimento a todas las aves en tres minutos.
Siga las pautas y las metas de peso recomendadas, y la uniformidad de las aves.
Aumente la cantidad de alimento con frecuencia durante el período de levante.
Asegúrese de que haya dos puntos de contacto en el ave: ambas piernas, las alas o los costados (se recomienda la manipulación mínima).
Maneje las aves para lograr la sincronización sexual entre los machos y las hembras.
Garantice el correcto manejo del alimento y la iluminación durante el inicio de la madurez sexual o la producción de huevos.
Aplique las relaciones de apareamiento recomendadas.
4. Manejo del ambiente de la granja
Motive el uso de los sistemas de sanitización de agua.
Use un sistema de agua cerrado.
Use una buena calidad de cama.
Maneje la calidad de la cama mediante la ventilación y la remoción de la cama apelmazada.
Retire objetos afilados.
Motive el ejercicio con la iluminación adecuada, perchas y slats (rejillas) de entrenamiento. Permita el acceso a las perchas a partir de los 28 días de edad.
Instale los slats (rejillas) a un máximo de 25 a 30 cm y manténgalas en buen estado.
Use rampas para ayudar a las gallinas a subir a los slats (rejillas).
Incorpore una baranda adecuada de descenso / perchas en el diseño de las cajas nido.


Garantice la bioseguridad apropiada en la planta de incubación y en la granja.
Garantice niveles altos de inmunidad materna usando los programas de vacunación apropiados.
Monitoreé y controle la coccidiosis y otros problemas intestinales.
Cuando use vacunas respiratorias más virulentas, primero exponga las aves a cepas intermedias o leves. Evite las reacciones “rodantes”.
Prevenga la contaminación de la vacuna y la aguja cambiando con frecuencia la aguja y el aplicador de la membrana del ala.
Use prebióticos y probióticos para ayudar a establecer la flora intestinal apropiada en forma temprana.

El tratamiento de la estafilococosis varía en eficacia, pero puede ser conveniente y ventajoso para el bienestar del ave. La mayoría de los S. aureus aislados de los pollos son sensibles a la penicilina, pero siempre se deben hacer pruebas de sensibilidad, porque la resistencia antibiótica es común.
La resistencia a la penicilina puede generarse rápidamente en las aves en tratamiento, por lo que puede ser beneficioso cambiar a otro antibiótico después de 5 a 7 días de tratamiento con penicilina.
Infección por estafilococo en la población de reproductoras DESCÁRGALO EN PDF
Otros antibióticos solubles en el agua que pueden ser efectivos incluyen la eritromicina, la lincomicina y las tetraciclinas, aunque no están disponibles en todos los países. Consulte con su veterinario avícola sobre el tratamiento con antibióticos.
Los antibióticos son más efectivos si se administran en la etapa temprana de la enfermedad.
Las infecciones establecidas — especialmente con artritis y osteomielitis— no responden a los medicamentos debido al nivel de daño ya causado en la articulación y el hueso, o a la dificultad para lograr la concentración adecuada de antibióticos en el lugar donde se concentra el daño. Lo mejor es retirar esas aves de la parvada.
Las soluciones a largo plazo más efectivas a la estafilococosis son centrar las PRÁCTICAS DE MANEJO EN LA PREVENCIÓN minimizando todos los factores que podrían contribuir a la infección estafilocócica.
Esto supone identificar y eliminar las posibles fuentes de estafilococos y reducir los factores que podrían aumentar la susceptibilidad de las aves a la infección.
Considere reducir la carga bacteriana general practicando la limpieza y desinfección óptimas, especialmente después de las parvadas que tuvieron una infección por Staphylococcus.
Además, promover las prácticas recomendadas de cría animal mejora el entorno de las aves y ayudar a reducir el riesgo de infecciones estafilocócicas.
REFERENCIAS BAJO CONSULTA DEL AUTOR.


La bioseguridad estricta es nuestro reto para prevenir, controlar y limitar la exposición a agentes bacterianos, víricos y parasitarios en todo tipo de granja avícola.
La planta de incubación es el punto de conexión en la producción de pollos de engorde, ya que en ella tenemos:
recepción de huevos de reproductoras de diversos orígenes nacimientos de pollitos de diversos orígenes envío de pollitos a diversos productores

La sanidad avícola está relacionada con la salud de las aves y la inocuidad de sus productos.
La bioseguridad es un conjunto de prácticas destinadas a prevenir, controlar y limitar la entrada o propagación de enfermedades.
La sanidad de la planta de incubación comienza con la sanidad de los huevos recibidos de las reproductoras, que se correlaciona con un plan de vacunación adecuada de las reproductoras y, sobre todo, con medidas como la desinfección y limpieza de las granjas y la prevención de los factores de riesgo que pueden causar daños a los huevos embrionados antes incluso de que lleguen a la planta de incubación.
El objetivo de la planta de incubación es lograr resultados de alta productividad, con un elevado número de nacimientos y la entrega de un pollito de alta calidad libre de patógenos que puedan poner en peligro su rendimiento en el campo.
Uno de los principales problemas sanitarios de las plantas de incubación es la contaminación bacteriana, que puede transmitirse de tres maneras:
1
Transmisión vertical (reproductorahuevo - pollito)
3
2
Transmisión horizontal, donde los microorganismos pueden propagarse dentro de las incubadoras y/o nacedoras a través del movimiento del aire, entre pollitos (meconio/ plumón/cáscara).

Transmisión cruzada, materiales contaminados (bandejas de incubación, cajas de nacimiento, cajas de transporte de pollitos).
Granja reproductora
Planta de incubación
Huevos fértiles
Pollitos
Granja pollos
La contaminación bacteriana en el pollito tiende a aumentar a medida que avanza el desarrollo embrionario y especialmente a medida que el pollito nace.
La tabla 1 muestra un análisis de E. coli en saco vitelino en tres fases:
huevos embrionados (entre 17 y 18 días),
huevos picoteados y
pollitos después de la eclosión.
Se observa que el porcentaje de positividad de E. coli aumenta de forma relativamente constante con el desarrollo y, sobre todo, después de la eclosión.
Tabla 1. Incremento de E. coli en saco vitelino durante incubación y tras la eclosión.
Representa que cuando tenemos un problema en la matriz y dentro de la planta se puede controlar y dirigir a productores específicos.
Demuestra que cuando no se tiene cuidado dentro de la planta, puede producirse una contaminación cruzada u horizontal y el problema puede extenderse a varios productores pollitos y huevos
La contaminación bacteriana es un parámetro importante que hay que monitorear porque causa grandes pérdidas durante el proceso de incubación y después de alojar a los pollitos.
Cuando hay problemas de contaminación, se producen pérdidas en la planta de incubación con un descenso de las tasas de nacimiento (aumento del porcentaje de huevos contaminados y mayores tasas de mortalidad inicial y final) y un mayor porcentaje de pollitos rechazados.

Los pollitos afectados por la contaminación bacteriana presentan mayores tasas de mortalidad en la primera semana, un mayor número de pollitos sacrificados y los pollitos asintomáticos presentan índices zootécnicos más bajos (peso, conversión alimenticia).
En la planta de incubación tenemos diversas bacterias como mesófilas, Shigella, Staphylococcus, entre otras, que al no ser controladas causan problemas en el proceso, pero destacaremos 3 bacterias que son monitoreadas constantemente dentro de las plantas y que causan daños cuando no hay un control efectivo.

En la planta de incubación, la vía horizontal es el principal medio de contaminación por E. Coli.
E. coli es una especie del género
Escherichia que pertenece a la familia
Enterobacteriaceae. Su temperatura ideal de crecimiento es 37ºC, pero puede variar entre 18 y 44 °C. Es fermentadora de glucosa y productora de gas.
E. COLI - APEC
E. Coli se divide en 3 categorías de cepas: comensales, patógenos intestinales y patógenos extraintestinales (APEC).
Los APEC están asociados a la colibacilosis aviar, que se manifiesta clínicamente a través de onfalitis, sepsis, aerosaculitis, peritonitis, síndrome de cabeza hinchada, salpingitis, entre otros. Se dividen en filogrupos (A, B1, B2, D y E), en el que el filogrupo B2 se considera el más virulento de los APEC.
Los pollitos infectados, los embriones muertos, las cáscaras de huevo y el plumón pueden ser fuentes potenciales de infección, dando lugar a contaminación entre los pollitos y el equipo.
Durante el periodo de incubación provoca un aumento del porcentaje de mortalidad embrionaria y la infección en los pollitos nacidos suele producirse entre las 24 y 48 horas después de la eclosión, con un aumento de la mortalidad del 5 al 20% en las primeras semanas.
La infección que afecta a los pollitos se denomina onfalitis, veremos sacos vitelinos infectados que pueden evolucionar a pericarditis y, posteriormente, a aerosaculitis y perihepatitis.
La salmonella es una bacteria Gram negativa. Se considera una zoonosis y es una de las principales causas de gastroenteritis. Siempre que se encuentra salmonella en plantas de incubación, hay que identificarla para poder rastrear mejor su origen.
La entrada de la bacteria puede ser por vía vertical desde los huevos de las reproductoras a los embriones y/o por vía horizontal a través de la contaminación de la cáscara, fómites (carros, bandejas y cajas de pollitos).
La contaminación por Salmonella en una planta de incubación no suele causar descensos significativos en los resultados de eclosión.
Puede producirse un descenso en la calidad de los pollitos, lo que se traduce en una reducción del índice de conversión alimenticia, desigualdades en el lote y aumento de la mortalidad. Además de la inviabilidad de tener aves positivas con serotipos zoonóticos.
Pseudomonas, especialmente Pseudomonas aeruginosa (P. aeruginosa) es una bacteria gramnegativa que se encuentra en suelos y aguas, y se ve favorecida en ambientes húmedos.
P. aeruginosa puede actuar como agente oportunista, siendo sus puntos de entrada las cáscaras de huevo mal desinfectadas, los trabajadores de producción y los fómites (bandejas y cajas). El control de esta bacteria es importante porque ha mostrado resistencia a los antibióticos y desinfectantes.
Desinfectantes 1 Desinfectantes 2 Desinfectantes 3
Tabla 2. Test de inhibición del crecimiento de P. aeruginosa en 3 desinfectantes diferentes a las concentraciones indicadas por el fabricante durante 3 tiempos de análisis. (BARBOSA et al., 2022)
Cuando está diseminada y no se controla, esta bacteria provoca:
Un descenso de la eclosión debido al aumento de huevos contaminados.
Aumento de la mortalidad embrionaria.
Aumento de los pollitos descartados (rechazados).
Fuerte mortalidad en las primeras semanas de los pollitos.
Disbiosis en los pollitos.
¿QUÉ
Para garantizar la salud de los pollitos, debemos prestar atención a varios puntos, siendo los principales las medidas de bioseguridad, que deben estar bien descritas y ser aplicables en el proceso, y las medidas alternativas para ayudar a mejorar la inmunidad y evitar la entrada de agentes.

Pérdida de rendimiento zootécnico. 1 2 3 4 5 6 7 8 9
AISLAMIENTO
CONTROL DEL TRÁFICO
HIGIENIZACIÓN
CUARENTENA/ MEDICACIÓN/ VACUNACIÓN
MONITOREO
ERRADICACIÓN DE ENFERMEDADES
AUDITORÍAS
EDUCACIÓN CONTINUADA
PLAN DE CONTINGENCIA
Todos los puntos de la bioseguridad deben cumplirse. Sin embargo, hay tres factores que son muy importantes en el funcionamiento diario de la planta de incubación para producir pollitos de alta calidad libres de patógenos que puedan interferir en su rendimiento zootécnico durante su desarrollo en el campo.
Los programas eficaces de limpieza y desinfección son vitales en las plantas de incubación, y algunos puntos son importantes:

¿Qué podemos monitorear?
Tiempo y dilución de los productos utilizados (detergentes y desinfectantes).
Tipo de suciedad que hay que eliminar.
Frecuencia de limpieza en los centros, pues cada centro requiere una frecuencia de higienización diferente en función del movimiento del proceso local.
Procedimientos descritos y aplicables en el proceso diario.
Establecer puntos críticos de control en el proceso
Las plantas de incubación deben monitorear la contaminación y el proceso de higienización para ver si el porcentaje de contaminación se estabiliza y el proceso de limpieza y desinfección está siendo eficiente.
Tabla 3. Puntos críticos evaluados mediante exposición de placas y hisopos para control de bacterias y hongos en planta de incubación.
Huevos y pollitos
Porcentaje de huevos contaminados en lotes en la transferencia y análisis de embriodiagnosis.
Porcentaje de mortalidad en la primera semana (cuando la causa es bacteriana).
Muestras de plumón y meconio.
Medio ambiente
Un punto muy importante es rellenar correctamente los formularios con observaciones sobre el entorno en el que se realiza el monitoreo.
Si el lugar estaba higienizado, si era justo después de la desinfección, si era una nacedora, si había pollitos nacidos, si era justo después del transfer, si había gente trabajando allí. Describe siempre bien el momento para poder comparar los resultados de momentos similares.
Exposición de la placa (bacterias y hongos)
Puntos importantes de evaluación
Túnel de aire principal
Túnel de aire de entrada de la incubadora
Sala de huevos
Máquinas de incubación
Sala de preparación de vacunas
Nacedora
Hisopos de superficie
Puntos importantes de evaluación
Máquinas de incubación
Nacedoras
Mesa de clasificación de huevos
Bandejas de incubación
Bandeja de eclosión
Caja de transporte de pollitos
¡¡¡Vamos a poner un ejemplo!!!
Informe de pollitos con mortalidad en la primera semana de vida debido a onfalitis.
El caso se rastreó con los datos del lote, los días de alojamiento, y de más lotes de los pollitos alojados, el material recogido en la planta de incubación (hisopos, plumón, cáscaras y saco vitelino pollito 1 día).
Los resultados de los análisis (tabla 4) mostraron un recuento de E. coli en los hisopos de la superficie de las nacedoras, en el residuo de plumón y en el saco vitelino.

Hisopos de la superficie - nac16
Hisopos de la superficie- Nacedora 21
Residuos – plumón, cáscara
Saco vitelino
Nacedora 16 1.700 o 1,7 x 103
Nacedora 21 2.500 o 2,5 x 103
Nacedora 27.000 o 2,7 x 104
Pollito 1 día 130.000 o 1,3 x 105
Tabla 4: Resultados de los análisis del recuento de E. coli del mismo lote en diferentes lugares durante el proceso de incubación.
La encuesta reveló que no todos los lotes padecían onfalitis ni procedían de los mismos reproductores. Los resultados muestran una falta de procedimientos de higiene en las nacedoras y un aumento de la contaminación en comparación con el saco vitelino, lo que sugiere una contaminación cruzada durante el proceso de nacimiento de los pollitos.
Formación continua
La planta de incubación debe mantener siempre un programa de formación para los nuevos empleados y de reciclaje para los más veteranos. Las personas se comprometen más con el éxito cuando se sienten parte del todo y comprenden el papel fundamental de cada una de sus tareas.

El uso de antibióticos como preventivo en los pollitos al nacer es una práctica que ya no se aplica, puesto que existe una gran preocupación por la resistencia bacteriana a los antibióticos y mejores prácticas para prevenir enfermedades.
Algunas alternativas incluyen:
Uso de prebióticos, probióticos o simbióticos en pollitos al nacer antes de ser enviados al campo: tiene por objetivo ayudar a colonizar el intestino desde el principio con bacterias que son buenas para la flora aviar, lo que ayudará a modular el sistema inmunológico y también promover una mejor integridad intestinal, lo que resulta en un mejor rendimiento zootécnico.
Estudio de los programas de vacunación en función de los retos de cada región: los buenos programas de vacunación promueven la mejora de la inmunidad materna y, en consecuencia, de la inmunidad de la progenie, así como el uso de vacunas en pollitos recién nacidos de acuerdo con los retos de la región.

Buenas prácticas de gestión del alojamiento, con acceso a una nutrición equilibrada, agua potable y temperatura adecuada.
La eficacia de la salud de los pollitos del primer día es una preocupación para la calidad del producto y los resultados de alto rendimiento.
Para conseguirlo, debemos estar al tanto de los procesos previos a la llegada de los huevos a la planta de incubación, así como participar en los procedimientos de medición y seguimiento dentro de la planta de incubación, de forma que la contaminación esté controlada y no ponga en peligro el producto final: el pollito.

Bacterias en la Planta de Incubación: Impacto y Estrategias de Control
DESCÁRGALO EN PDF

Aumentar los índices de incubabilidad y mejorar la uniformidad de los pollitos son objetivos clave para cualquier incubadora. La amplia gama de soluciones Prinzen permite automatizar por completo el proceso para eliminar el error humano y asegurar una incubabilidad superior. Combinando un manejo cuidadoso con la velocidad, logramos que la recogida de huevos para incubar sea rápida, sencilla y segura.
Las soluciones Prinzen se integran en las principales etapas del proceso, optimizando cada una de ellas:
– Transporte y admisión de huevos
– Pesaje, clasificación y selección
– Empacado y colocación en bandejas
– Salida y carga de bandejas en carros

¿Conoces todas las soluciones de Prinzen? Contacta con nosotros
Empacadoras, pesadoras y clasificadoras, marcadoras de huevos, apiladores, paletizadores, cargadores de bandejas, y mucho más.


Alejandro Blanco Mozo
Area Sales Manager 660 731 629
alejandro.blanco@vencomaticgroup.com
Vencomatic Ibérica S.L.
977 331 908
info@vencomatic.es C/ Pintor Fuster, 21 43205 REUS (Tarragona)

La producción avícola sin jaulas se vuelve más sencilla y competitiva
En un sector avícola cada vez más orientado hacia los sistemas fuera de jaulas, SKA se consolida como un socio estratégico para los avicultores que buscan soluciones alineadas con las nuevas normativas europeas.
Con más de 70 años de experiencia y una producción completamente Made in Italy, la empresa ha sido pionera en el desarrollo de sistemas de cría sin jaulas.



Esto nos permite ofrecer soluciones que no solo cumplen plenamente con la normativa de bienestar animal, sino que también están diseñadas para facilitar de forma concreta el trabajo del avicultor.
Nuestros aviarios han sido concebidos pensando tanto en el bienestar de las aves como en la eficiencia y comodidad del granjero:
ATHENA es el sistema aviario multinivel diseñado para acompañar a las pollitas en cada fase de su desarrollo, preparándolas de forma gradual y eficaz para la vida en aviario.

Garantizan un fácil acceso
Promueven la autonomía en el trabajo
Simplifican las tareas diarias
Reducen la necesidad de mano de obra, incluso en instalaciones de alta densidad.
Nuestra colaboración de larga trayectoria con el distribuidor español Exafan nos permite ofrecer a los avicultores soluciones aviarias fiables, personalizadas y adaptadas a los desafíos actuales del sector, acompañándolos en cada etapa de la transición desde sistemas tradicionales hacia modelos más avanzados.


Es la solución ideal para quienes buscan un sistema flexible, eficiente y conforme a las normativas europeas, que facilite al máximo el trabajo del operador y permita alcanzar el máximo rendimiento en el menor tiempo posible.
Gracias a su diseño funcional —que favorece un aprendizaje rápido por parte de las pollitas—, su facilidad de uso y una estructura que permite dividir el lote en distintas áreas, minimizando el riesgo biosanitario, ATHENA es altamente recomendable por los veterinarios.

En países como Italia, importantes empresas de genética avícola ya han elegido los aviarios de SKA como solución para sustituir el 100 % de sus sistemas en jaula, apostando por un

Por estas razones, Hy-Line Genetics
Italia ha elegido ATHENA como sistema para sus criaderos de pollitas.
Estructura modular y autoportante, independiente de la nave y adaptable a cualquier configuración


Plataformas móviles que favorecen el movimiento vertical y la autonomía de las pollitas, estimulándolas a saltar y desplazarse libremente para acceder a comederos y bebederos.
También simplifican la gestión diaria; por ejemplo, en los primeros días, pueden usarse como barreras para agrupar los pollitos y facilitar las operaciones de vacunación
Compatible con diferentes tipos de equipos
El sistema ATHENA permite una gestión fluida y progresiva de las pollitas, mejorando su familiarización con el entorno aviario y facilitando la transición al sistema de voladeras.
La posibilidad de bajar las plataformas en los primeros días de vida facilita actividades fundamentales como la vacunación.

GEMMA
Solución ideal para una puesta eficiente y rentable
Diseñado para maximizar la rentabilidad durante la fase de puesta, GEMMA L es el sistema aviario que garantiza bienestar animal y optimización del espacio.
Es apto para gallinas ponedoras convencionales, ecológicas o camperas (free range).
Perchas y posaderos que estimulan el comportamiento natural y mantienen activas y saludables a las gallinas
Nidales centrales y recolección de huevos lateral
Sistema de secado de estiércol
Iluminación LED de intensidad gradual para estimular el movimiento de forma natural
Alimentación en dos niveles y cintas automáticas de recolección

Sistema de expulsión mediante elevación del piso, para una gestión higiénica y eficiente

La estructura está diseñada para facilitar el desplazamiento de los animales, respetando su etología y cumpliendo con las normativas sobre bienestar de las gallinas ponedoras.

Cada módulo mide 240 cm de largo por 266 cm de ancho, dispuesto en filas longitudinales, y se entrega con sistemas de alimentación en dos niveles y cintas automáticas de recolección.
Incluye también un sistema de expulsión mediante elevación del piso, para una gestión higiénica y eficiente.
Eficiencia, confort y bienestar en una sola estructura

Diseñado para quienes buscan altas prestaciones en espacios reducidos, SIRIO es el sistema aviario compacto que combina funcionalidad y bienestar animal.
Módulos de Nidos y Aviarios integrados en una estructura modular
Estructura de acero con paredes de madera y techo accesible, ideal para una combinación de durabilidad y sostenibilidad
Ventilación optimizada para mantener condiciones ambientales ideales
Configuraciones personalizables con módulos nido de pared o centrales
SIRIO está equipado con un sistema de expulsión con piñón y cremallera, que permite una gestión fluida y eficiente de los animales, mejorando la higiene y reduciendo el estrés.
El diseño estimula el comportamiento natural de los animales, permitiéndoles moverse libremente y razzolar, con acceso cómodo a comederos y bebederos.
Un sistema que combina confort, funcionalidad y bienestar, perfecto para las necesidades del avicultor moderno.

Todos los sistemas SKA integran soluciones para optimizar el trabajo diario:
Sistema Convoy para centralizar el transporte de los huevos
Diseñado para reducir los desperdicios desde el primer día
Nacido en 2024, ERA es el nuevo comedero para pollos de carne, diseñado para responder a las necesidades del mercado avícola actual.

Barras configurables que protegen los huevos de golpes
Reducción de los tiempos de recolección para un considerable ahorro de mano de obra
resultados concretos
Las soluciones se traducen en beneficios tangibles:
Aumento de la productividad
Reducción de los costos operativos
Mejora del bienestar animal
Optimización del espacio
Control preciso de cada fase productiva

Fruto de un estudio atento del sector, ERA combina funcionalidad innovadora y diseño inteligente para reducir pérdidas, simplificar la gestión y mejorar el rendimiento del criadero.
Altura reducida (48,5 mm), ideal para los pollitos desde el primer día
Sistema de overflooding para una alimentación continua en las fases iniciales
Borde anti-desperdicio para reducir las pérdidas de pienso

En España, la colaboración entre SKA y Exafan representa una alianza estratégica que une experiencia, innovación y conocimiento del sector avícola.
Gracias a esta sinergia, ofrecemos al mercado español soluciones completas y personalizadas en sistemas aviarios, acompañando a los productores en la transición hacia modelos de alojamiento sin jaulas.
Regulación en tres niveles (12, 21, 30 mm) durante la fase adulta
Capacidad hasta X animales por plato, para optimizar el espacio
Limpieza fácil gracias al plato giratorio y sistema de desenganche rápido
Exafan, como socio de confianza y distribuidor exclusivo de SKA en el país, aporta su cercanía al cliente, su capacidad técnica y su profundo conocimiento del terreno.
Por su parte, SKA contribuye al proyecto con tecnología de vanguardia y una sólida trayectoria internacional avalada por décadas de experiencia.
¿Necesitas más información y deseas hablar con un experto? Contacta a nuestro referente Exafan, Luis Bermejo, en luisbermejo@exafan.com
2027 está a la vuelta de la esquina, di adiós a las jaulas DESCÁRGALO EN PDF



Pedro Gil Sevillano Veterinario Consultor
El huevo es un alimento de origen animal con grandes propiedades nutricionales y culinarias. Se caracteriza por su alta densidad nutritiva, una excelente calidad-precio y ser un ingrediente habitual en la alimentación del hombre.

El huevo forma parte del sistema de reproducción del ave y contiene todos los compuestos, nutrientes y no, necesarios para el desarrollo del embrión.

Un huevo está formado por una yema central (31%) rodeada por el albumen o clara (58%) y envuelto todo ello por una cáscara externa (11%).
El huevo tiene unos contenidos moderados en calorías y ácidos grasos (AG) saturados. Contiene una proteína con un perfil de aminoácidos ideal, una alta proporción de ácidos grasos (AG) insaturados, todas las vitaminas excepto la vitamina C y minerales esenciales para las necesidades del organismo, conservados y protegidos por la cáscara.
La cáscara es una estructura compleja que contribuye al sistema de defensa frente a la contaminación microbiana del huevo y es un excelente envoltorio natural que preserva el valor nutricional del huevo entero.

Podemos definir como alimento funcional aquel cuyo consumo contribuye a aportar beneficios sobre la salud, por encima del aporte estrictamente nutricional.
Presenta compuestos identificados como fisiológicamente activos y con efectos positivos demostrados para mantener y potenciar la salud, así como la aparición de determinadas patologías.
El huevo contiene numerosos compuestos con actividad biológica que ejercen un papel en la terapia y prevención de enfermedades crónicas e infecciosas.
Se han descrito la presencia de compuestos con actividades microbianas, inmunomoduladores, propiedades antioxidantes, anticancerígenas y anti hipertensivas, entre otras (Huopalahti et al., 2007; Kovac-Nolan et al.,2005). Algunas sustancias como la lisozima y avidina de la clara o inmunoglobulinas (IgY) y fosfolípidos como la lecitina de la yema, se producen a escala industrial. Es importante conocer el papel del huevo entero como alimento funcional, ya que es ingrediente habitual de nuestra dieta.

Los compuestos con demostrado y aceptado valor funcional son la colina, luteína y zeaxantina. Además la vt.E y los AG poliinsaturado (AGPI) omega -3, presentes en cantidades importantes en huevos enriquecidos. Aporta algunos nutrientes que benefician el estado de salud y bienestar de las personas, más allá del concepto funcional del huevo (Applegate, 2000; Meister et al., 2002).
Destaca su moderado contenido energético, 71 kcal en un huevo de 50 g, que corresponde a 142 Kcal/100g de huevo comestible.
El huevo aporta una alta proporción de las necesidades diarias de una persona en nutrientes esenciales y una baja proporción de sus necesidades en calorías.
La densidad nutricional del huevo en relación a otros alimentos proteicos como la carne, es muy favorable en referencia a los AGPI, el hierro, las vitaminas B2, B12, A, E y folato (Codony, 2002).
Su consumo es especialmente indicado en personas que ingieren una limitada cantidad de alimento y/o energía y necesitan asegurar una ingesta de nutrientes esenciales (personas mayores, niños, dietas de adelgazamiento,etc.).
Un huevo aporta, repartidos entre la yema y la clara, unos 6,4 g de proteína.
Principalmente destacan proteínas como la ovoalbúmina (54%) y la ovomucina (11%) responsables de la consistencia del albumen, y la lisozima (3,4%) por sus propiedades antibacterianas.
La composición proteica del huevo es considerada de alto valor biológico, ya que contiene todos los aminoácidos esenciales y en la proporción adecuada “ideal”, para cubrir las necesidades de las personas.
Es una fuente de proteína altamente digestible ya que más del 95% de la proteína del huevo es digerida y resulta disponible para cubrir las distintas necesidades del organismo (Millward, 2004).
El huevo es una fuente concentrada de leucina desempeñando un papel fundamental en el control de la síntesis de tejido muscular y el control de la saciedad (Layman y Walker, 2006).
Los huevos son también interesantes en la alimentación de las personas que padecen gota ya que al no aportar purinas éstas no se pueden transformar en ácido úrico en el organismo (Ortega, 2002).





El huevo contiene aproximadamente un 11% de fracción grasa (4,9 g por huevo de 50 g) depositada exclusivamente en la yema. De la fracción grasa el 66% son triglicéridos, un 28% son fosfolípidos y un 5% colesterol.
Del porcentaje de ácidos grasos en el huevo entero, un 3% son AG saturados AGS, un 4% son AG monoinsaturados (AGMI) y un 2% son AGPI del cuál un 1,4% corresponde al ácido linoleico esencial. Tanto la cantidad como la relación entre AG tiene importante repercusión en la salud.
En el mercado encontramos huevos cáscara enriquecidos en AGPI omega-3, y esto es posible gracias a la incorporación de a ceite de linaza o pescado en la ración de las gallinas. Esto permite aumentar los niveles de AG eicosapentaenoico (EPA) y docosahexaenoico (DHA).
Su consumo ha demostrado reducir el riesgo de enfermedades cardiovasculares y mejorar las funciones visuales y mentales (Baucells et al., 2000).
El contenido medio de colesterol en el huevo de gallina es de 410 mg por 100 g de huevo entero (205 mg en un huevo de 50 g) y se deposita en la yema. Se ha demostrado que existe una relación entre el riesgo de enfermedades cardiovasculares y la presencia de altos niveles de colesterol, en la circulación sanguínea integrado en lipoproteínas de baja densidad (LDL).
Pero más que el colesterol de la dieta, como responsable de los niveles circulantes, la cantidad y el tipo de grasa ingerida es la que produce elevados niveles de colesterol LDL en paralelo con el incremento del consumo de AGS (American Heart Association AHA, 2000)
Diferentes estudios han demostrado que no existe una relación entre el consumo de huevos y la aparición y desarrollo de enfermedades cardiovasculares (Hu et al., 1999;Kritchevsky,2004; McNamara, 2002; Nakamura et al., 2006; Natoli et al., 2007; Qureshi et al., 2007).
Otros compuestos del huevo como los AGPI, antioxidantes (carotenoides, vit. E, selenio), fosfolípidos (lecitina y esfingomielina), vitaminas del grupo B y folato pueden contribuir a contrarrestar el posible efecto negativo del consumo de colesterol.


La colina es imprescindible para mantener la integridad de la membrana y para el normal desarrollo y funcionamiento cerebral.
Tanto la colina como el ácido fólico son donadores de grupos metilo y junto con la vitamina B12, evitan el aumento de la concentración de homocisteína en sangre (aumento relacionado con el incremento de riesgo vascular), ya que facilitan la transformación de homocisteína en metionina.
El consumo de colina mejora la función mental en personas con déficit de acetilcolina como son los enfermos de Alzheimer y personas mayores con demencia presenil.
Hay evidencias de que la fosfatidilcolina o lecitina así como la esfingomielina de la yema del huevo, tienen efectos anticolesterolémicos y antiaterogénicos ya que reduce la absorción de colesterol (Jiang y col., 2000; Noh y Koo, 2003).
Un huevo contiene aproximadamente 250-300 mg/100 g de colina y la ingesta recomendada es de 550 y 425 mg/día para hombres y mujeres, respectivamente.
Luteína y Zeaxantina, son pigmentos carotenoides que se encuentran en la yema del huevo. Junto con las xantofilas rojas, son las responsables de la coloración de la yema del huevo. Se ha demostrado su importante efecto antioxidante, antimutagénico y anticarcinogénico (Ribaya-Mercado y Blumberg, 2004; Sajilata et al., 2008).
La ingestión de luteína y zeaxantina ha demostrado que reduce el riesgo de cataratas y previene la degeneración macular. También ejercen una acción antiinflamatoria con un importante papel en la prevención de enfermedades coronarias y desarrollo de algunos tipos de cáncer (Dwyer y col., 2004;Ribaya-Mercado y Blumberg, 2004).
El huevo es el único alimento de origen animal que aporta luteína y zeaxantina y la biodisponibilidad es superior a la de algunas fuentes de origen vegetal (Chung y col., 2004; Handelman et al., 1999).
Se ha demostrado que el contenido de luteína y zeaxantina aumenta de forma directamente proporcional a su concentración en el pienso de las gallinas.
El huevo contiene todas las vitaminas con excepción de la vitamina C, y satisface entre el 10-15% de las necesidades diarias de vitaminas A, D, B2, niacina, B12, ác. pantoténico y biotina (Tortuero, 2002).
La vitamina A es importante para el normal funcionamiento y desarrollo celular y esencial para la visión.
En concreto el huevo representa el 10% del CDR. Aporta cantidades apreciables de vitamina D o colecalciferol, así como de su metabolito 25-(OH)-colecalciferol, de mayor actividad biológica (Carbajal, 2005). El consumo de huevo constituye un 15% de la ingesta total de este nutriente y es importante en personas que tienen limitado el acceso a la luz solar.
La vitamina E o tocoferol es conocida por su gran poder antioxidante. El huevo representa el 5% de la CDR. Es uno de los nutrientes que ha sido comprobado y conseguido su enriquecimiento a través de la alimentación de la gallina. (Galobart et al., 2002).
La vitamina B2 o riboflavina implicada en diferentes rutas metabólicas, contribuye en un 7,8% a la ingesta global de la población española.
La vitamina B12 o cianocobalamina interviene en la formación de células sanguíneas y del tejido nervioso. Un huevo puede llegar a cubrir el 68% del CDR.
El ácido fólico tiene efectos parecidos a la colina en su relación con la gestación. El huevo permite una contribución del 8% del consumo total de este nutriente en España.
La biotina tiene importancia dentro del metabolismo energético y con implicaciones a nivel de tejidos epiteliales. El consumo durante la lactación está recomendado para contrarrestar las pérdidas a través de la leche.
Es importante recordar, que solo en el caso del huevo crudo, la avidina (proteína que se inactiva con el tratamiento térmico) impide la absorción de la biotina.

FELX BELT - cinta transportadora de huevos ELX huevos


De diseño flexible para adaptarse a todas las necesidades
Permite largas distancias sin transferencias intermedias
Mantiene intacto el huevo durante el transporte sin roturas ni fisuras
Fabricado con material duradero para una larga vida útil
Fácil limpieza
Sistema de ventilación - Satrun Five E-LINE istema - E-LINE
Ventiladores regulados Saturn FIVE con alta eficiencia energética
Alto rendimiento con flujos hasta 63.000 m³/h y presiones hasta 150 Pa
Válvula de mariposa de plástico que elimina corrientes y reduce pérdidas energéticas
Posibilidad de instalar filtro de luz
Larga vida útil y resistencia a la corrosión gracias a Munters Protect, acero inoxidable

Sistema de ventilación - ED36 HE E-LINE istema de HE




Solución energéticamente eficiente que permite ahorrar hasta un 50 % de electricidad con la versión E-line
Durabilidad superior con el revestimiento Munters
Protect Bajo mantenimiento
Adecuado para una ventilación mínima
Alta capacidad del caudal de aire
Garantía de calidad y cuenta con la certificación ISO
9001
Tel: 977 75 54 60 comavic@comavic.com Av. Constantí, 63 Nave 1, 43420 Reus

Disponible en dos anchos diferentes y combinables en una misma nave
100% de la puesta en el sistema en una misma cinta

de huevos con mayor capacidad NUEVA CINTA

Dos niveles de nidal para una mejor distribución de las aves durante las horas de puesta, permitiendo un reparto uniforme de la producción
Destacan la contribución del zinc (4,7%), selenio (9,7%), hierro (10,5%) y calcio (3,9%), a la ingesta diaria recomendada. El zinc aportado por el huevo s e absorbe mejor que el de los alimentos de origen vegetal (Sanstrom y col., 1987). También es destacable la riqueza en selenio en su papel frente al estrés oxidativo.
Está demostrado que la composición nutricional del huevo puede variar debido a distintos factores como la alimentación, la genética y la edad de las gallinas. Sin embargo, cambios importantes con repercusión práctica a nivel nutricional, únicamente se han descrito en los lípidos ( ácidos grasos omega-3,CLA), las vitaminas liposolubles, como la E, y algunos minerales (yodo, cromo y selenio) lo que permite la producción de huevos enriquecidos en diferentes componentes de interés nutricional y/o funcional.


J.M. Watier 2 , A. Mahieu 2 *, A. Canin 2 , R. Domitile 2 , M. Aoun 2 , F. Laurent1 *, D. Liebhart 3 , M. Hess3, A. Greuter 2
1 INRAE, Universidad de Tours, ISP, equipo AIM, F-37380, Nouzilly, Francia
2 IDENA, 21, rue du moulin, F-44880, Sautron, Francia
3 Vetmeduni, Vienne, Universidad de Veterinaria, Veterinärplatz 1, A - 1210 Wien, Austria
RESUMEN
La histomoniasis es la principal enfermedad a la que se enfrentan todos los productores de pavos desde la prohibición de los fármacos antihistamínicos específicos en 2003.
Además, la coccidiosis y la enteritis inespecífica son enfermedades que pueden agravar la enfermedad de la cabeza negra debido a los problemas de salud intestinal que causan.
Por lo tanto, parecía apropiado desarrollar una solución que pudiera prevenir todos estos problemas al mismo tiempo.

Publicaciones recientes han puesto de relieve la reaparición de la enfermedad de la cabeza negra, no sólo en pavos, sino también en pollos reproductores y gallinas ponedoras camperas.
Debido a la interrupción o al acceso limitado a moléculas específicas y a la dificultad de fabricar una vacuna, parecía que una solución de origen vegetal podría ser una posible vía de avance.

Diversos experimentos in vitro, en colaboración con institutos de investigación, han demostrado que una elección adecuada de extractos vegetales y aceites esenciales podría conducir al diseño de un producto eficaz capaz de prevenir simultáneamente todos estos trastornos intestinales.
El principal reto para la salud intestinal de los pavos es combatir las principales amenazas parasitarias, principalmente la histomoniasis y la coccidiosis, y las infecciones bacterianas como E. coli y Clostridium, preservando al mismo tiempo la microflora positiva.
El equilibrio adecuado de esta microflora es muy importante para preservar la integridad del epitelio intestinal y, en consecuencia, para una tendencia positiva de la digestibilidad.
Los medicamentos contra la histomoniasis están prohibidos en la Unión Europea desde hace mucho tiempo y, desde entonces, los productores de pavos se han enfrentado a brotes regulares de la enfermedad de la cabeza negra, con niveles variables de mortalidad y degradación del rendimiento en todos los casos (síntomas clínicos o subclínicos).
Durante más de 50 años, la profilaxis de la coccidiosis se basó en el uso intensivo de anticoccidiósicos. Posteriormente, la aparición de poblaciones parasitarias resistentes a los anticoccidiósicos fue inevitable debido a su uso generalizado como aditivo en la alimentación de las aves de corral.
También se presentarán aquí las investigaciones llevadas a cabo para diseñar un producto fitogénico para la gestión de los riesgos asociados a coccidiosis de los pollos y la disbiosis que se produce al mismo tiempo.
Para ello, hemos trabajado con el equipo del INRAE , capaz de cultivar parásitos de Eimeria en cultivos celulares específicos.
En colaboración con el INRAE (Instituto Nacional Francés de Investigación para la Agricultura, la Alimentación y el Medio Ambiente), evaluamos 150 principios activos, principalmente de origen natural (extractos de plantas o aceites esenciales), pero también compuestos aromáticos sintéticos presentes de forma natural en el medio ambiente.

Estos compuestos se seleccionaron por su efecto citotóxico directo sobre la fase de diseminación del parásito (ooquiste) o por su capacidad, sola o combinada, de limitar la invasión y/o el desarrollo en las células epiteliales.
Por otra parte, estudiamos con otro socio investigador (Universidad Vetmundi de Viena) un medio de probar bioactivos específicos, en la misma línea que el estudio anterior.
El objetivo de este estudio era investigar el efecto de las sustancias vegetales sobre el crecimiento y la viabilidad de Histomonas meleagridis cultivadas in vitro.
Por último, en cuanto a la parte antibacteriana de la solución, se ensayaron determinadas mezclas bioactivas contra una amplia gama de bacterias, Clostridia, Enterococcus y Lactobacillus en particular, en colaboración con la Universidad de Lille (Francia).
Además de estos tres estudios experimentales con socios científicos, también se incluyen los resultados de investigaciones específicas del departamento de I+D de IDENA (elección final de los compuestos, elección de los adyuvantes, elección de los emulsionantes para producir la microemulsión).
del estudio sobre las histomonas
El objetivo del proyecto era estudiar el efecto de sustancias vegetales sobre el crecimiento de Histomonas meleagridis in vitro.
Para ello, se seleccionaron diez sustancias (sustancias aromáticas y sintéticas y una mezcla de distintas sustancias) a dos concentraciones diferentes (0,5% y 2,5%, 100 y 500 ppm respectivamente para la concentración bioactiva), suministradas por IDENA (Sautron, Francia).

de Medicina Avícola y Piscícola de la Universidad de Medicina Veterinaria de Viena.
El proceso de investigación fue el siguiente:


Extractos de plantas de IDENA
Incubación 24, 48 y 72h



Efecto antihistomonas por recuento de H.meleagridis viables mediante una cámara Neubauer de recuento celular

En colaboración con el INRAE, IDENA evaluó una amplia gama de bioactivos contra los agentes de la coccidiosis aviar realizando un cribado in vitro.
El objetivo era evaluar su capacidad para limitar la invasión y/o replicación de los parásitos en las células epiteliales intestinales.
Para adaptar este estudio a la especificidad de Eimeria del pavo, consideramos que el modo de acción de los bioactivos sobre Eimeria en este estudio (aquí E. tenella) no es específico de una especie de Eimeria, sino común al filo Apicomplexa y, por tanto, a los que afectan a la especie del pavo.
Efecto de los compuestos IDENA en la esporulación de ooquistes
Los animales infectados excretan en sus heces ooquistes no esporulados, que deben esporular para ser infecciosos para otros congéneres. Varios compuestos de IDENA redujeron significativamente la esporulación de ooquistes de Eimeria tenella en un 90% a diluciones de hasta 30 ppm.
Inoculación oral
10.000 ooquistes/pollo
Extracción cecal ooquistes/puri cación. Tratamiento con productos IDENA durante 72h
Filtración 50 µm de ooquistes esporulados y no esporulados y recuento

Efecto de los compuestos IDENA sobre la invasión de esporozoitos en cultivo celular
El equipo del INRAE desarrolló parásitos transgénicos que expresan β-galactosidasa (β-Gal) para facilitar la evaluación de este proceso.
Se preincubaron varias dosis de compuestos IDENA con esporozoítos (estadio invasivo) y se cuantificó su capacidad para invadir monocapas de células epiteliales mediante la actividad β-Gal.
Se seleccionaron determinados compuestos por su capacidad para reducir la invasión celular en un 50%.


Efecto de los compuestos IDENA sobre el desarrollo del parásito en cultivo celular
El INRAE produjo cepas transgénicas específicas de E. tenella para estudiar el desarrollo del parásito in vitro y determinar con precisión la concentración inhibitoria semi-máxima (IC50) de cada compuesto.
% viabilidad
% desarrollo


Para diseñar bioactivos eficaces, llevamos a cabo un cribado en profundidad de principios activos colaboración con la Universidad de Farmacia de Lille (Francia).
El objetivo era determinar la concentración mínima inhibitoria (CMI) por dilución en agar, del mismo modo que para las moléculas antibióticas.

En estos ensayos se probaron una treintena de combinaciones de principios activos para determinar su capacidad de inhibición de las cepas bacterianas.
Probamos varios principios activos (aceites esenciales, extractos de plantas o mezclas de principios activos) en diferentes cepas de Clostridium y en flora positiva como los lactobacilos.
Difusión
El estudio arrojó cuatro resultados principales.
Gracias a estas pruebas, pudimos seleccionar 3 aceites esenciales interesantes y calcular su dosis de incorporación efectiva.
La determinación de las concentraciones mínimas inhibitorias (CMI) sobre bacterias anaerobias patógenas y beneficiosas se llevó a cabo en la Universidad de Lille (Francia). Estas diferentes cepas se probaron de la siguiente manera:
30 MUESTRAS DE ACEITES ESENCIALES
Clostridium perfringens (CP)
Clostridium difficile (CD)
Bacterias negativas (BN)
Bacterias Positivas (BP)
Elección de las cepas:
18 cepas patógenas

Clostridium perfringens (CP)
5 bacterias negativas (NB)
7 bacterias positivas (PB)
Sin efecto Efecto fuerte
Cepas probadas:
Bacterias patógenas -> Clostridium perfigens(CP) / Clostridium perfringens (CP)
Bacterias Negativas (BN) -> Enteroccocus feacalis, gallinarum and faecium
Bacterias Positivas (BP) -> Lactobacillus gallinarum, crispatus er aviarus / Bifidobacterium pullorum
Parte de las otras propiedades del componente:
Como sabemos que los procesos de infección e infestación siempre generan inflamación, hemos añadido extractos de plantas cuidadosamente seleccionadas que tienen reconocidas propiedades antioxidantes y antiinflamatorias.

Otros medios de transformación permiten mejorar la eficiencia de los componentes:
Para reducir las desventajas de los aceites esenciales presentes en el producto final, se ha implementado una tecnología específica basada en la elección de emulsionantes y la aplicación de una emulsión de alto cizallamiento.
Eficacia sobre Histomonas
En este estudio, la CML (concentración letal mínima) mostró una reducción significativa (p<0,05) de células vivas de H. meleagridis sin su recrecimiento en un cultivo posterior con medio fresco. Esto se descubrió añadiendo FORKEY y la sustancia n.° 6 en concentraciones de 500 y 50 ppm de ingredientes activos respectivamente.
Este proceso específico permite una biodisponibilidad óptima de los principios activos, una mejor penetración de coccidios (Eimeria), Histomonas y bacterias por los principios activos y una mayor estabilidad del producto.
Tabla
Eficacia sobre coccidiosis
Se generaron tres cepas recombinantes del parásito E. tenella para probar la eficacia de los 150 compuestos de la biblioteca IDENA contra todas las etapas del ciclo de vida del parásito.
Seis compuestos fueron capaces de limitar la esporulación de E. tenella en más del 90%. Tres compuestos limitaron la invasión en al menos un 50% con un índice de selectividad (IE = relación eficacia/toxicidad) de

Los resultados respecto a las etapas de invasión, desarrollo y esporulación se resumen en la Tabla 1 a continuación:
El ratio SI (selectivity Index =eficacia/ ratio toxicidad) se usa para seleccionar el ingrediente activo más efectivo y el menos tóxico para las células epiteliales
Tabla 1. Efectos de los compuestos Idena (solos o mezclados) sobre la invasion, el Desarrollo y la esporulación de Eimeria tenella subre las celulas epiteliales.
La siguiente tabla resume los resultados del estudio realizado en la Universidad de Lille, mostrando las actividades inhibitorias (en CMI) sobre cepas seleccionadas de Clostridium perfringens, bacterias “negativas” (Clostridium, Enterococcus) y bacterias positivas (como los lactobacilos), lo que lleva a una elección pertinente de una mezcla con los ingredientes activos.
En conclusión, seleccionamos una mezcla de ingredientes (mezcla #4) que tiene un fuerte efecto antibacteriano contra Clostridum spp. y un bajo efecto nocivo contra las bacterias beneficiosas, con una concentración inhibitoria mínima media de 6,2 ppm y superior a 512 ppm.
Todos estos estudios experimentales han demostrado que es posible formular una solución alternativa y específica capaz de gestionar los riesgos asociados a la presencia de estos parásitos contribuyendo así a mejorar resultados.

Un efecto sobre parásitos para detener el desarrollo de Histomonas meleagridis, para romper el ciclo parasitario de Eimeria, y un efecto antiséptico intestinal para combatir las bacterias (principalmente C. perfringens)
Al utilizar este producto durante varios años, algunas empresas de producción de pavos han probado la eficacia de alimentar a los pavos con soluciones alternativas en el alimento en lugar de los antiguos medicamentos antihistomoniasis que ahora están prohibidos, sin encontrar casos clínicos de histomoniasis.
Gestión de los riesgos asociados a Histomonas y coccidios mediante plantas y sustancias aromáticas DESCÁRGALO EN PDF

FORKEY es una combinación original de ingredientes activos para fortalecer el equilibrio intestinal.
FORKEY , botanicos con propiedades vermífugas y antiprotozoarias, interrumpe el ciclo de parásitos como Heterakis gallinarum y Histomonas meleagridis . Combate infecciones bacterianas con acción antiséptica contra Clostridium y E. coli . Reduce el riesgo de coccidiosis limitando Eimeria , y fortalece la inmunidad aviar protegiendo la mucosa digestiva.

Con el uso creciente de vacunas de vector viral en todo el mundo, el tema de las unidades formadoras de placa (UFP) continúa siendo un término no comprendido en la industria avícola.
Con frecuencia, se asocia a los niveles altos de UFP de las vacunas de herpesvirus de pavo (HVT) de forma imprecisa con una mayor protección y, lo que es peor, se usan los niveles de UFP para determinar la tasa de dilución posible de una vacuna.

Isabel M. Gimeno, DVM, PhD
Profesora, Universidad estatal de Carolina del Norte Contenido de Zoetis

Sin embargo, las UFP no son una forma de medir la eficacia de una vacuna y no existe un número mágico de UFP que garantice la protección. La cantidad de UFP necesaria para alcanzar la mejor eficacia depende del producto.
La cantidad de UFP por dosis se relaciona con la medida en la que el virus de la vacuna está adaptado al cultivo celular. Aunque todas las vacunas de HVT comerciales derivan de la cepa FC-126 aislada de Witter, cada fabricante de la vacuna posee su propio


la dosificación de una vacuna de HVT y no diluirla según su nivel de UFP. Cualquier cambio en la dosis recomendada podría llevar


Se administró una HVT convencional y tres rHVT in ovo (IO) en una dosis reducida de 1500 UFP. La dosis recomendada para cada vial está indicada arriba de las barras. PI = índice de protección, cuando se expone a la cepa 648A del virus de la enfermedad de Marek de mucha más virulencia (vv+MDV) a un día de edad. Las letras minúsculas diferentes sobre las barras indican que las diferencias encontradas fueron significativamente diferentes (P <0,05).
Figura 1. Replicación de la rHVT en pollos a los que se les administró 1500 UFP in ovo.
De manera alternativa, el aumento de la dosis podría no ser bueno en algunos casos. Se ha demostrado que agregar una dosis muy alta de la vacuna contra la enfermedad de Marek (EM) (es decir, CVI988) cuando se la mezcla con una HVT recombinante (rHVT) provoca una reducción de la replicación del rHVT, lo cual enfatiza la importancia de seguir las recomendaciones del fabricante (Figura 2).
Las vacunas contra la EM están asociadas a células, es decir que hay una mezcla de células infectadas (5 % a 20 %) y no infectadas (80 % a 95 %) en el vial, en lugar de partículas virales infecciosas libres. Por ende, son extremadamente frágiles (el virus muere si la célula muere) y existe una gran variabilidad en la dosis de la vacuna.

Un estudio demostró que la variabilidad de UFP entre las dosis al momento de la reconstitución en cada vial oscila entre el 10 % y el 34 %. Las calificaciones de UFP son promedio.
No se debe pensar que, porque una vacuna tenga una UFP particular, esto significa que cada dosis única tendrá esta UFP (Figura 3).
Efecto del tiempo y el mezclado en la variabilidad de la dosis de la vacuna. Las barras azules (0) representan las UFP por dosis de vacuna individual en condiciones óptimas; las barras rojas (60-con mezcla) representan las UFP por dosis de vacuna 1 hora después de la reconstitución con mezcla continua; las barras negras (60-sin mezcla) representan las UFP por dosis de vacuna individual 1 hora después de la reconstitución sin mezcla.

Figura 2. Es necesario que se optimicen los protocolos para maximizar la replicación de la rHVT para garantizar la protección contra la EM.

Se administró una HVT recombinante (rHVT) en la dosis recomendada (RD), ya sea in ovo (IO) o a un día de edad por vía subcutánea (SC), solo o en combinación con CVI988 en dos dosis distintas (SRD = dosis estándar recomendada o DD = dosis doble). PI = índice de protección, cuando se expone a la cepa 648A del virus de la enfermedad de Marek de mucha más virulencia (vv+MDV) a un día de edad. Las letras minúsculas diferentes sobre las barras indican que las diferencias encontradas fueron significativamente diferentes (P <0,05). Variabilidad de la dosis de una vacuna contra la EM al momento de la reconstitución. Cada barra representa una dosis de la vacuna. 100 RDderHVTIORDderHVTSCRD+DDderHVT +CVI988IORD+SRDderHVT+CVI988IORD/DDderHVT/
Figura 3. Variabilidad de la dosis de la vacuna.

cantidad máxima de UFP.
Con el tiempo, esta cantidad comienza a disminuir. La manipulación y la mezcla inadecuadas, así como el uso de antibióticos en combinación con una HVT, pueden causar niveles de UFP muy incongruentes. En algunos casos, es posible que los pollos no reciban la dosis suficiente para que les otorgue protección.


En general, cada producto de HVT (ya sea convencional o recombinante) es único en su capacidad para otorgar protección contra la EM, mientras que el rHVT tiene la ventaja de proporcionar inmunidad contra otras enfermedades virales.
Sin embargo, el almacenamiento, la manipulación y la administración de las vacunas son factores clave, y es importante seguir las instrucciones del fabricante. Para aprovechar al máximo el programa de una vacuna de vector viral, el enfoque debe darse en la manipulación, la preparación y la administración oportuna de la vacuna, factores que están bajo el control de los veterinarios avícolas.

Referencias bajo consulta al autor
La importancia real de los
DESCARGUE PDF


de las
Todas las marcas registradas son propiedad de Zoetis Services LLC o una compañía o un licenciatario relacionados, a menos que se indique lo contrario.
© 2024 Zoetis Services LLC. Todos los derechos reservados. MM-37306







TÚ TIENES EL INSTINTO DE PROTEGER. NOSOTROS EL DE PROTEGER RÁPIDAMENTE.
Introducing Poulvac® Procerta™ HVT-IBD. La protección temprana lo es todo en la producción avícola, por ello Zoetis ha creado su novedosa vacuna vectorizada para que manejes el tiempo a tu favor. El resultado de nuestros últimos avances científicos es Poulvac® Procerta™ HVT-IBD, que protege de forma completa y rápida frente a virus virulentos, muy virulentos y variantes1-4 de la enfermedad de Gumboro. En

En la avicultura existen muchos obstáculos y desafíos en términos económicos y sanitarios.
La avicultura en Portugal crece día a día, se construyen nuevas naves, hay inversiones en tecnología e innovación, pero existen plagas y agentes infecciosos que dificultan ese crecimiento y reducen su rentabilidad.
Hoy en día es impensable criar aves de corral sin un programa sanitario robusto, tanto en vacunación como en bioseguridad.



Sin embargo, el objetivo de este artículo no es hablar de programas de vacunación ni de buenas prácticas de bioseguridad, sino compartir los desafíos que puede representar para nosotros una de las plagas más frecuentes en las instalaciones avícolas, Alphitobius diaperinus.
Esta plaga se puede observar dentro de las instalaciones cerca de las ventanas, debajo de los comederos y en las esquinas de las naves.
Alphitobius diaperinus se considera una plaga porque puede ser un reservorio de varias enfermedades y causar grandes daños a las instalaciones avícolas.
Desde hace más de 20 años, este insecto ha sido identificado como reservorio de Escherichia coli.
Las larvas y adultos de Alphitobius pueden excretar Escherichia coli en sus heces hasta por 10 días, diseminando así esta bacteria por todo el pabellón, colonizando a las aves que acaban entrando en contacto con este agente.

Los pollitos que ingieren larvas de Alphitobius diaperinus infectadas con Escherichia coli tienen hisopos cloacales positivos para esta enterobacteria.
Además, tenemos el problema de que este insecto propaga patógenos entre ciclos de producción.
MN Skov y sus compañeros (2004) observaron Alphitobius positivos para Salmonella y Campylobacter durante los ciclos de producción y durante el intervalo entre producciones.
La positividad para Salmonella en Alphitobius diaperinus durante el periodo de vacío coincidió con la positividad en las aves para Salmonella en las 2 producciones consecutivas.
La similitud genética entre la Salmonella aislada en los insectos y en las aves se confirmó mediante electroforesis en gel, y se encontró similitud, lo que refuerza la idea de que este insecto funciona como reservorio de Salmonella.


La misma situación se observó para el agente Campylobacter Todas las muestras de Alphitobius positivas para Campylobacter estaban relacionadas con grupos de pollos positivas.

Sin embargo, no se observó ningún Alphitobius diaperinus positivo para Campylobacter durante los períodos vacíos, lo que no respalda la idea de que este insecto funcione como reservorio de esta enfermedad entre producciones sucesivas.
Alphitobius diaperinus es un vector de enfermedades y es importante que su población esté controlada para mitigar el impacto de las enfermedades que este insecto puede transmitir.
Para controlar este insecto es importante conocer su ciclo de vida y su comportamiento en la naturaleza.
Alphitobius diaperinus está presente tanto en instalaciones avícolas ovopoyéticas como creatopoyéticas y actualmente se encuentra distribuido por todo el mundo.
Todo su ciclo de vida ocurre dentro de las instalaciones avícolas, estando presente en la cama y el estiércol de las aves.
Los adultos de Alphitobius diaperinus ponen huevos que contienen de 8 a 11 larvas.
El tiempo de desarrollo de cada fase depende en gran medida de la temperatura ambiente. Las larvas se convierten en pupas y luego en adultos.
El ciclo de vida de este insecto, desde la puesta de huevos hasta la edad adulta, es de 34 a 38 días a una temperatura de 30°C.
Por debajo de 30°C el desarrollo se ralentiza, alcanzando un máximo de 165 días a 20°C.

A temperaturas inferiores a 20°C el desarrollo de este insecto se detiene HUEVOS




PRIMER CEBO PULVERIZABLE CONTRA MOSCAS LISTO PARA USAR, EXTREMADAMENTE RÁPIDO Y EFICAZ
DESCRIPCIÓN
Seclira® Fly Bait es el primer cebo listo para usar contra moscas domésticas y de establo. Se puede aplicar rápida y fácilmente en superficies no porosas sin necesidad de preparación del producto.
COMPOSICIÓN
Dinotefurán 0,5 %
USO
Cebo pulverizable en latas de 500 ml y 250 ml
En el interior de salas de ordeño, naves porcinas, establos, naves avícolas y lugares similares sometidos a requisitos de higiene elevados.
En el interior de edificios de explotaciones agrícolas y ganaderas (almacenes, trasteros, gallineros y otras salas).
MODO DE EMPLEO Y DOSIS
Tratamiento de banda o en puntos localizados sobre estructuras existentes no porosas, así como también placas preparadas para la aplicación.
A 30 cm desde la superficie, pulverizar durante 3 segundos por metro lineal tratado.
Dependiendo del nivel de infestación, 500 ml de Seclira® Fly Bait pueden cubrir una superficie de entre 400 m2 y 600 m2
Protege las explotaciones agrícolas y ganaderas y los establecimientos urbanos, reduciendo el estrés y las posibles enfermedades causadas por las moscas en personas y animales.
Solución rápida, eficaz y lista para usar.
Solo hay que pulverizarlo en la superficie.
Cebo incoloro e inodoro.
Efecto duradero durante al menos 6 semanas.


Un producto de:

BASF Española S.L.
Can Ràbia, 3-5 08017 Barcelona +34 93 496 40 00 pestinfo@basf.com https://pest-control.basf.com/es

Una hembra adulta puede vivir de cuatro meses a un año, poniendo alrededor de 3,5 huevos por día, alcanzando generalmente un total de 200 a 400 huevos durante su vida.

Alphitobius diaperinus se alimenta de estiércol y restos de alimento que puedan caer sobre la cama.
Cuando se retira el estiércol, estos insectos suben y entran en las estructuras e incluso salen de las unidades y se dispersan del sitio, e incluso se han encontrado en áreas residenciales.

En casos de infestación extrema, las aves pueden alimentarse de Alphitobius diaperinus, consumiendo menos alimento, lo que resulta en una disminución del crecimiento y del aumento de peso vivo.
La infestación extensa también causa daños a los materiales de aislamiento debido a que las larvas excavan en busca de lugares para pupar.

En las naves de puesta con jaulas, las larvas prepupas perforan las vigas de soporte de madera, degradando las vigas y el aislamiento, comprometiendo la integridad estructural de la instalación con el tiempo.
Este daño puede reducir en gran medida la eficacia del aislamiento y comprometer el flujo de aire en las naves, obligando a los mecanismos de calefacción y ventilación a trabajar más, aumentando los costos para el productor.
La menor eficacia de las estructuras de las naves y, eventualmente, la necesidad de reemplazar componentes, debido a la presencia generalizada de Alphitobius diaperinus en la producción avícola, puede tener impactos económicos inconmensurables.

Fotografía 1. Muestra de la degradación provocada por el insecto en los bienes materiales de la granja
En cuanto al control de estos insectos, en el vacío, entre producciones, recomienda pulverización de las paredes y pisos de los aviarios
Organofosforados
Piretroides permetrina),
Neonicotinoides imidacloprid)
Espinosinas
Siendo igualmente importante eliminar por completo la cama y toda la materia orgánica del aviario.
Se aplicó cipermetrina en las juntas entre e l suelo, la pared y en las grietas a lo largo del pabellón.
Además de esta práctica, introdujimos el uso de un desinfectante que, además de glutaraldehído y un amonio cuaternario, tiene un 10% de cipermetrina en su composición, lo que nos permite aplicar este insecticida en una mayor zona de la nave.

Al inicio de la producción, la población de Alphitobius diaperinus parecía estar controlada, probablemente gracias a la aplicación del desinfectante con insecticida.
Sin embargo, se ha observado resistencia a insecticidas específicos después del uso del mismo ingrediente activo durante varios años consecutivos y resistencia cruzada a insecticidas con el mismo mecanismo de acción,
por lo que el uso rotativo de diferentes ingredientes activos debería ser una práctica para retrasar la aparición de resistencia.
En nuestra realidad, hasta hace unos cuatro años sólo aplicamos cipermetrina al 10% mediante pulverización después de lavar y desinfectar las naves antes de poner el
Sin embargo, a medida que avanza el ciclo, vuelven a observarse individuos en la cama y las paredes.
Esto impide saber con certeza si realmente se está controlando la población, por lo que sería recomendable realizar un seguimiento objetivo y no basarse únicamente en la observación visual.
Lo que se sugiere en la literatura es el uso de tubos de cartón con secciones de cartón enrolladas y que posteriormente son colocadas dentro de pequeños trozos de tubo de PVC, que por su morfología serían atractivos para que las larvas



Estas trampas se distribuirían por toda la cama y se dejarían durante 1 semana. Pasado este tiempo se recogerían y congelarían para poder matar a los Alphitobius y poder sacarlos del cartón y contar el número de estos insectos.
Sólo con un trabajo de seguimiento a lo largo de varios ciclos de producción podremos comprender realmente la eficacia de nuestro enfoque en el control de Alphitobius y el tamaño de esta plaga en el aviario.
Los Alphitobius son omnipresentes en las explotaciones avícolas y prácticamente todos los criadores hacen algo para controlarlos, la cuestión en este momento será entender si estas acciones son efectivas y cómo cuantificar las pérdidas económicas debido a la presencia de estos insectos en las explotaciones avícolas.

Laura Rodríguez
Departamento Técnico de AMBiotec
En la avicultura de producción, la salud digestiva es un determinante fundamental de la rentabilidad y la sostenibilidad.

Un tracto gastrointestinal (TGI) funcional no solo asegura la absorción eficiente de nutrientes, sino que también modula la respuesta inmune, protege contra patógenos y contribuye a un mejor bienestar general de las aves.
La optimización de la salud digestiva requiere una comprensión profunda de los factores que influyen en su funcionamiento y la implementación de estrategias integrales que aborden estos factores de manera efectiva.


La microbiota intestinal aviar es un ecosistema microbiano complejo, ejerce una influencia significativa en la digestión, la inmunidad y la protección contra patógenos. Un desequilibrio en la microbiota (disbiosis) puede comprometer la salud digestiva y por ende, el rendimiento productivo.
La microbiota intestinal está compuesta por una diversidad de microorganismos, incluyendo bacterias, hongos, virus y protozoos.
Los microorganismos beneficiosos, tales como Saccharomyces, Lactobacillus y Bifidobacterium, fermentan carbohidratos no digeribles, produciendo ácidos grasos de cadena corta (AGCC) que modulan la fisiología intestinal, mejoran la absorción de nutrientes y fortalecen la barrera intestinal.
La edad, la dieta, el estrés, el uso de antibióticos y las condiciones ambientales pueden alterar la composición y función de la microbiota
El estrés calórico, por ejemplo, es uno de los factores que más puede afectar de forma negativa la microbiota y la integridad intestinal.
Sustratos no digeribles que promueven el crecimiento selectivo de bacterias beneficiosas.
Los fructooligosacáridos (FOS), manano oligosacáridos (MOS) y β-glucanos son ejemplos comunes.

Microorganismos vivos que, al ser administrados, confieren un beneficio para la salud del huésped. La selección de cepas específicas con eficacia comprobada es fundamental.
Los postbióticos son compuestos bioactivos producidos por microorganismos inactivos o sus componentes. Son el resultado de la actividad metabólica de microorganismos (probióticos), o de su lisis. Estos compuestos pueden mejorar la salud intestinal, la inmunidad y otras funciones del organismo.

Compuestos naturales de origen vegetal. Pueden actuar como moduladores de la microbiota intestinal en animales, favoreciendo el desarrollo de bacterias beneficiosas y reduciendo la presencia de patógenos. Esto se logra mediante la acción de sus componentes bioactivos, que pueden inhibir el crecimiento de bacterias patógenas o estimular el desarrollo de bacterias beneficiosas
La mucosa intestinal representa una barrera física y funcional que previene la translocación de patógenos y toxinas al torrente sanguíneo, protegiendo al organismo de su invasión.
La mucosa está compuesta por una capa de células epiteliales, unidas por uniones estrechas. Estas uniones regulan la permeabilidad intestinal, controlando el paso de moléculas y microorganismos.
El estrés oxidativo, las infecciones, las micotoxinas y las dietas desequilibradas pueden comprometer la integridad de la mucosa, incrementando la permeabilidad intestinal y la inflamación.

Nutrientes Clave: La glutamina, la arginina y el ácido butírico son esenciales para la reparación y el mantenimiento de las células epiteliales.
Antioxidantes: Vitaminas E y C, selenio y polifenoles pueden reducir el estrés oxidativo y proteger la mucosa.
Piensos complementarios y aditivos alimentarios: Los ácidos orgánicos y aceites esenciales pueden mejorar la integridad de la mucosa al reducir la inflamación y promover la proliferación celular.

DEL SISTEMA
Las infecciones bacterianas, virales y parasitarias representan una amenaza constante para la salud digestiva avícola, pudiendo comprometer el rendimiento productivo y la rentabilidad de las explotaciones, es por ello por lo que es esencial tener un plan de control para minimizar los riesgos.
Medidas estrictas de higiene, control de vectores y vacunación son fundamentales para prevenir la entrada y propagación de patógenos.
Fitobióticos: Presentan propiedades antimicrobianas y antiinflamatorias que contribuyen al control de infecciones y la modulación de la respuesta inmune.
Ácidos Orgánicos: Reducen el pH intestinal, inhibiendo el crecimiento de bacterias patógenas y favoreciendo la proliferación de bacterias beneficiosas.
Bacteriófagos: Virus que infectan y destruyen bacterias específicas, ofreciendo una alternativa prometedora para el control de infecciones bacterianas.
Péptidos Antimicrobianos: Moléculas que interfieren con la membrana celular de las bacterias, impidiendo su crecimiento y proliferación.
El uso de vacunas para prevenir enfermedades infecciosas comunes en aves de corral es esencial para proteger la salud digestiva y el rendimiento productivo.
El uso racional de antibióticos debe reservarse para casos de necesidad y bajo supervisión veterinaria, dada la creciente preocupación por la resistencia antimicrobiana.

La dieta ejerce una influencia significativa en la salud digestiva de las aves, modulando la composición de la microbiota, la integridad de la mucosa y la respuesta inmune.
La utilización de ingredientes de alta calidad y digestibilidad es fundamental para asegurar una adecuada absorción de nutrientes y minimizar la fermentación de sustratos no digeridos en el intestino grueso. La suplementación de la dieta con enzimas (fitasas, proteasas, carbohidrasas) puede mejorar la digestión de nutrientes complejos, incrementando la disponibilidad de nutrientes y reduciendo la carga de sustratos no digeridos en el intestino grueso.
Un tamaño de partícula adecuado puede mejorar la digestión y reducir la incidencia de problemas digestivos, al optimizar el contacto entre las enzimas digestivas y los nutrientes.
BILANTUL SOLUCIÓN: UN COMPONENTE
INTEGRAL PARA EL EQUILIBRIO DIGESTIVO
El monitoreo y la mitigación de la presencia de micotoxinas en los alimentos son esenciales para prevenir los efectos adversos sobre la salud digestiva y el rendimiento productivo. La utilización de adsorbentes de micotoxinas puede reducir la absorción de estas toxinas y minimizar su impacto.
En el contexto de estas estrategias avanzadas, la inclusión de productos específicos como Bilantul Solución ofrece beneficios adicionales.
Bilantul Solución, formulado con moléculas estandarizadas procedentes de extractos vegetales ha demostrado ser eficaz en la modulación de la microbiota intestinal, el fortalecimiento de la integridad de la mucosa y la reducción de la carga patógena en aves de corral.

Mecanismo de Acción: Los componentes activos de Bilantul Solución actúan sinérgicamente para mejorar la salud digestiva. Los compuestos organosulfurados y fenólicos así como su pH ácido reducen el pH intestinal, inhibiendo el crecimiento de bacterias patógenas y favoreciendo la proliferación de bacterias beneficiosas. Los aceites esenciales que lo componen además, presentan propiedades antimicrobianas y antiinflamatorias, contribuyendo al control de infecciones y la modulación de la respuesta inmune. Asimismo, los componentes prebióticos de los que están formados fomentan el crecimiento de bacterias beneficiosas, mejorando el equilibrio microbiano y la producción de AGCC.
Evidencia Científica: Estudios in vitro e in vivo han demostrado la eficacia de Bilantul Solución en la mejora de la salud digestiva avícola. Estos estudios han revelado que Bilantul Solución puede reducir la carga de bacterias patógenas en el intestino, mejorar la integridad de la mucosa y fortalecer el sistema inmune de las aves.
Implementación Práctica: Bilantul Solución puede ser administrado a través del agua de bebida. La dosis y la duración del tratamiento deben ser ajustadas en función de las necesidades específicas de cada granja y bajo la supervisión de un técnico o un nutricionista avícola.

La salud digestiva es un factor crítico en la producción avícola moderna. La implementación de estrategias integrales que aborden la microbiota intestinal, la integridad de la mucosa y la gestión de desafíos infecciosos es esencial para optimizar la salud digestiva y el rendimiento productivo.
La implementación efectiva de estrategias de salud digestiva requiere un enfoque integral y una monitorización continua para asegurar la consecución de los objetivos planteados.
La realización de necropsias, análisis de heces y pruebas de laboratorio permite evaluar la salud del TGI y detectar posibles problemas.
La adaptación de las estrategias en función de los resultados de la monitorización y las condiciones específicas de cada granja es fundamental para optimizar los resultados. El trabajo en estrecha colaboración con veterinarios, nutricionistas y otros

Bilantul Solución, con su formulación única y su mecanismo de acción sinérgico, representa una herramienta valiosa para mejorar la salud digestiva avícola. Al incorporar Bilantul Solución en un programa de salud digestiva bien diseñado, los productores avícolas pueden mejorar la salud, el bienestar y el rendimiento de sus aves, contribuyendo a una producción avícola más sostenible y eficiente.



Fitobiótico

• Controla la proliferación de parásitos como coccidios, criptosporidios y otros nematodos y cestodos.
• Reduce los efectos de las toxinas de bacterias patógenas como clostridios.
• Evita procesos diarreicos en edades tempranas producidas por coccidios, criptosporidios y otros parásitos.
• Mejora los resultados zootécnicos debido a una mejora en el aprovechamiento de nutrientes.
• Evita procesos infecciosos de todo tipo por el gran nivel de anticuerpos neutralizantes que genera.
• Disponible en frascos de 250 ml., botellas de 1 L., garrafas de 5 L. y Jarricane de 20 L.






Agroalimentaria Manchega de Biotecnología, S.L. C/ Río Montiña, 5 Pol. Ind. Sta. Mª de Benquerencia 45007 Toledo (España)
Teléfono: 925 672 642 info@ambiotecsolutions.com
www.ambiotecsolutions.com

En la actualidad, es evidente que la genética disponible en ponedoras comerciales nos ofrece animales con una enorme persistencia de puesta, una evidente mayor resistencia a procesos patológicos y unos consumos siempre moderados de pienso.
Evidentemente, en estas circunstancias, el alargamiento de la vida comercial de estos animales es una práctica cada vez más común, de modo que muchos lotes de gallinas pueden superar las 110 semanas de vida sin mayores problemas.

Además, el coste de mantenimiento en granja es bastante estable a lo largo de la vida del ave, por lo que en primera instancia el análisis económico viene dado por la relación entre la puesta de los animales y el consumo de pienso. Desde este punto de vista, parece que alargar la vida comercial de las gallinas es siempre un buen negocio.
Todo en la vida tiene una cara B, y en este caso hablamos de aquellos factores que pueden significar que este análisis no sea tan evidente. Entre ellos,
una mayor mortalidad de las aves como consecuencia de problemas esqueléticos, hepáticos o digestivos,
un incremento de las posibilidades de problemas bacterianos de riesgo para los consumidores o
una reducción de la calidad de los huevos producidos.
Especialmente, este último factor puede ser determinante a la hora de decidir eliminar un lote de gallinas que aún mantienen una buena tasa de postura, especialmente cuando, por normativas de los diferentes países, o por implicaciones de otra índole, la muda no sea una opción disponible.
No por repetido es menos cierto que la persistencia de la producción de huevos de calidad de las aves depende, en muy gran medida, de las condiciones en las que se produce la cría y recría de las mismas, y de la entrada en producción. Es interesante comprobar cómo acontecimientos que tienen lugar en las primeras semanas de vida tienen tan altas implicaciones 100 semanas más tarde.
Asegurar un desarrollo correcto del animal en el arranque, donde el objetivo no es solamente obtener un determinado peso, si no lograr animales con un desarrollo digestivo, esquelético y muscular suficiente.
Para ello, no sólo hay que centrarse en las características nutricionales del alimento, que también es fundamental, además, hay que conseguir consumos suficientes del mismo en los animales.
No basta que el pienso tenga de todo lo que el ave precisa, es fundamental que se lo coma.
Mejorar en lo posible las condiciones ambientales de la instalación, vigilar las densidades, extremar los estímulos y, sobre todo, lograr un alimento con una presentación física atractiva para las gallinas (cuidado con dietas en harinas bajas en grasa y muy pulverulentas).
Tratar de evitar pérdidas de peso a lo largo de la cría, ajustando lo mejor posible los manejos a lo largo de la misma, estimulando los consumos y vigilando especialmente las densidades. En este periodo la formación y estabilización del hueso cortical es fundamental para evitar problemas posteriores de mortalidad.
Finalmente, alcanzar el principio de la puesta con un peso y un consumo ajustado a las especificaciones de las estirpes, y acompañar el principio de la producción con dietas formuladas, en cuanto a su densidad, a los consumos reales de los animales.
Calcio y Fósforo, con sus condicionantes de calidad
En general el hueso contiene aproximadamente 98 a 99% del calcio total del cuerpo y un 80 a 85% del total del fósforo.
El hueso de las gallinas ponedoras está formado por el hueso estructural (cortical y trabecular) que se forma normalmente antes de las 18 semanas de vida, y el hueso medular que se forma a partir de las 18 semanas con la madurez sexual de las pollitas.
Nuestro mayor interés se encuentra en el hueso medular, ya que es el más activo metabólicamente y es la principal reserva de calcio de disponibilidad inmediata.

Cuando las gallinas ponedoras envejecen su capacidad para absorber Ca por el intestino y su movilización desde los huesos se reduce en forma significativa. Por eso es muy importante constituir una buena reserva de Ca en el hueso medular para que esté disponible en momentos críticos de alta demanda.
Esta reserva se moviliza hacia la glándula uterina para formar la cáscara, con la mediación de la hormona paratiroidea (PTH), que es secretada por la glándula paratiroides cuando los niveles de Ca en la sangre disminuyen.
Este proceso está también regulado por la Vitamina D (hormona calcitriol) 1,25(OH)2D3. Ambas hormonas actúan en conjunto movilizando Ca desde el hueso medular, estimulando la reabsorción renal de Ca y aumentando la absorción intestinal del mismo. La reabsorción renal del Ca se intercambia con la eliminación de fósforo.

Colecalciferol (Vitamina D3)
Alimentación
Vitamina D3 (peces, carnes)
Vitamina D2 (suplementos)
25-hidroxivitamina D3

1,25-dihidroxivitamina D3
En las ponedoras es absorbido entre el 40 al 60 % del Ca ingerido y disminuye con la edad. La retención del Ca absorbido aumenta de 40 al 80% durante la formación de la cáscara.
En general, los requerimientos de Ca aumentan con la edad mientras que los de P disminuyen, de ahí la importancia de mantener el fósforo disponible de la dieta bajo y tener cuidado con los márgenes de seguridad muy amplios que nos pueden llevar a excesos de fósforo, lo cual afectará la calidad de la cáscara.
La cáscara del huevo está formada, aproximadamente, por un 95% de carbonato cálcico, mayoritariamente en forma de cristales de carbonato de cálcico, y un 5% de material orgánico, formado por una matriz orgánica y las membranas de la cáscara.

La deposición del Carbonato cálcico en la cáscara del huevo ocurre en la glándula uterina a partir del Calcio disponible en sangre y mediante la formación de bicarbonato por la hidratación del CO2, que está mediado por la enzima Anhidrasa carbónica, que tiene como cofactor al Zn.
El estrés por calor, así como también altos niveles de sodio, cloruro y las sulfamidas, pueden inhibir la actividad de la enzima anhidrasa carbónica afectando la calidad de la cáscara.

El tamaño de la partícula del Carbonato de Calcio influye en forma importante en la calidad de la cáscara y en recuperar el hueso medular y disminuir la osteoporosis en las gallinas ponedoras.
Cuando las gallinas ponedoras envejecen su capacidad para absorber Ca por el intestino y su movilización desde los huesos se reduce en forma importante.
A medida que la gallina envejece y debido al incremento en el tamaño del huevo el porcentaje de peso de la cáscara y el grosor de la misma tienden a disminuir.
También se presenta disminución en la cantidad de cutícula y deterioro de las características estructurales de la cáscara.
Se considera que una ponedora requiere un mínimo de 2 gr/día de Ca para formar la cáscara del huevo y unos 0,6 gr/día para mantenimiento. Entonces, tiene un requerimiento mínimo de 2,6 gr/día de Calcio.
Considerando un 55% de eficiencia en la absorción, se requieren 4,73 gr de Calcio al día y si el consumo de alimento es de 110 gr al día, el contenido de Calcio en el alimento deberá ser de 4,3% de Ca.
En climas calientes cuando las gallinas jadean por estrés calórico se produce una baja de carbonato en la sangre lo que genera cáscaras frágiles, por tal motivo puede ser positivo añadir Bicarbonato de Sodio en el alimento.
El Magnesio forma parte de la matriz mineral del hueso y de la cáscara del huevo, permitiendo el arreglo ordenado de los cristales de Hidroxiapatita, lo que les da estabilidad a estas estructuras.
Cantidades muy elevadas de hierro, aluminio y magnesio pueden interferir con la absorción de fósforo formando fosfatos insolubles.
1. Influencia del peso del huevo sobre el peso de la cáscara y su contenido de Calcio.

Conmemoramos 80 años de excelencia en genética avícola, impulsando la productividad y calidad en la producción de huevos.
Agradecemos la confianza de nuestros clientes y aliados a lo largo de este camino.
Atte. Equipo H&N International

Solución integral frente a la Salmonella con Ceva y sus innovadores equipos de vacunación.

Consulta Ficha Técnica
El Zinc es un cofactor de la Anhidrasa carbónica que es esencial para la formación de la cáscara del huevo y de enzimas esenciales para el funcionamiento del sistema inmune, de tal modo que una deficiencia de Zn puede generar deterioro de la calidad de la cáscara.
El Manganeso entre otras funciones interviene en la formación del cartílago de los huesos y de las membranas internas y la matriz orgánica de la cáscara del huevo lo que sirve de soporte para la deposición de la matriz mineral y le da flexibilidad lo cual mejora la integridad y la resistencia de la cáscara del huevo.
Vitaminas implicadas
La Vitamina D está implicada en el metabolismo del calcio y el fósforo trabajando en conjunto con la parathormona y la paracalcitonina.
La vitamina C es esencial entre otras funciones para la biosíntesis de colágeno que forma parte de la membrana interna de la cáscara del huevo y le da resistencia y elasticidad. También ayuda a reducir el estrés al reducir los niveles de cortisol en la sangre.
1 2 3 4 5
Se recomienda que un mínimo de 75% de las partículas del Carbonato de calcio, tengan un grosor entre 2 a 4 mm para que se queden retenidas en la molleja y se disuelvan lentamente de tal modo que la gallina disponga de Ca durante las horas de formación de la cáscara del huevo, que ocurre principalmente en la noche.
Incluir metabolitos de la Vitamina D3 tales como el 25-(OH)2D3 y 1,25-(OH)2D3 que se encuentran disponibles comercialmente.
Sustituir parte de Óxidos y/o Sulfatos por fuentes “orgánicas” de Zinc y Manganeso, que son más biodisponibles.
Incluir Vitamina C sobre todo en ponedoras que se encuentren bajo condiciones de estrés calórico.
Formular dietas que traten de mantener un tamaño de huevo que no sea excesivamente grande para tratar de preservar una buena calidad de la cáscara.
El hígado es el órgano por excelencia con mayor carga metabólica de la gallina ponedora.

Produce ácidos biliares de suma importancia para la emulsión y digestión de las grasas, lo cual favorece también la absorción de vitaminas liposolubles, pigmentos etc.
Metaboliza los carbohidratos a glucosa como fuente de energía y puede almacenarla como glucógeno. Puede también producir glucosa a partir de algunos aminoácidos y del glicerol de los triglicéridos.
Produce lípidos a partir de carbohidratos mediante la lipogénesis, siendo este un mecanismo de alta demanda en la ponedora para producir todos los lípidos que requiere para la formación de la yema del huevo.
Metaboliza lípidos para formar triglicéridos y también los oxida mediante la beta oxidación, si bien esta se realiza también en otros tejidos como el músculo, riñones etc.
Sintetiza proteínas a partir del pool de aminoácidos circulantes provenientes de la digestión y absorción de las proteínas.
Interviene en la función de eritropoyesis.
Es un importante depósito de vitaminas, A, D, E, K, B12. Esta última, a diferencia de las otras vitaminas hidrosolubles, se puede almacenar en forma importante.
Tiene una importancia relevante en la eliminación y/o transformación de compuestos tóxicos (xenobióticos) fármacos, micotoxinas, insecticidas etc.















Por su demostrada eficacia y seguridad, LIDERFEED es el ÚNICO GENUINO PROMOTOR DE CRECIMIENTO español aprobado por EFSA para la UE
(Register of Feed Additives pursuant to Regulation (EC) Nª 1831/2003 – Annex I.List of Additives https://ec.europa.eu/food/sites/food/files/safety/docs/ animal-feed_additives_eu-register_1831-03.pdf)



Principales problemas que afectan al hígado
Un aumento en la producción de Especies Reactivas de Oxígeno (ERO) en relación a los antioxidantes, puede iniciar reacciones oxidativas en cadena y peroxidación lipídica que causan daños graves a las células. Hay que evitar el uso de grasas rancias y usar buenos niveles de antioxidantes tanto en los aceites como en el alimento.
Las ERO, anión superóxido y peróxido de hidrógeno, son reducidas por reacciones catalizadas por las enzimas Superóxido Dismutasa (SOD) y Glutatión Peroxidasa (GSH-Px) respectivamente.
Los oligoelementos cobre (Cu), hierro (Fe), manganeso (Mn) y zinc (Zn) forman parte de la estructura proteica de la SOD y el selenio (Se) forma parte de la GSH-Px.
Síndrome de hígado graso
El hígado graso o esteatosis hepática es una acumulación de grasa en el mismo, a la necropsia se observa un hígado generalmente agrandado, pálido o amarillento y friable al tacto. Puede llegar a presentar zonas hemorrágicas y petequias, pudiendo llegar a generar rotura hepática y la muerte.
El hígado graso no funciona adecuadamente y dependiendo del grado de incidencia será el nivel de afectación sobre la producción y la calidad de los huevos y en general sobre la salud de las gallinas.
Causas principales del hígado graso
Elevado consumo de energía debido a alimento muy concentrado y/o consumo de alimento elevado. Con alimento granulado o en migajas generalmente hay más consumo que con alimento en harina.
Dietas muy altas en carbohidratos con lo cual aumentará la necesidad de producción de grasa para la yema del huevo y esto aumenta el esfuerzo metabólico del hígado.
Alta temperatura ambiental que disminuye los requerimientos energéticos.
Aves en jaulas con menores necesidades de mantenimiento tienen más predisposición que aves en piso.
Presencia de micotoxinas en el alimento que afectan negativamente el hepatocito y en general el funcionamiento hepático, pudiendo también generar fragilidad capilar entre otros.
Dietas con bajo contenido de colina.
Alimento con grasas rancias cuyo impacto negativo dependerá también de los niveles de Vitamina E y/o Selenio.
Presencia de micotoxinas en el alimento, principalmente de Aflatoxinas que son las que presentan mayor hepatotoxicidad.
Principales consecuencias de un estado anómalo del hígado
Baja de producción de huevos, aves obesas con abundante acumulo de grasa abdominal, puede haber incremento de mortalidad por rotura hepática.
Incremento en el número de huevos con cáscara frágil al estar disminuida la transformación hepática de la Vitamina
D3 al metabolito 25(OH)D3 el cual requiere una hidroxilación adicional en el riñón para obtener la forma activa que es 1,25(OH)2 D3.
Pérdida de color de la cáscara, en gallinas marrones, por déficit de producción de protoporfirina.
Formas de reducir el problema de hígado graso
Formular un alimento isoenergético y que aporte la mayor parte de los lípidos que requiere la gallina para formar la yema del huevo disminuirá la presión metabólica sobre el hígado, en lugar de tener que sintetizar dichos lípidos a partir de carbohidratos.
Usar alimento en harina y no en migajas ni granulado. Regular el consumo de alimento.
Uso de grasa y/o aceites, así como subproductos con alto contenido de grasa y/o aceite residual libres de rancidez.

Suplir cantidades suficientes de Vitamina E y Selenio (Se) de ser posible “orgánico”.
Agregar metabolitos de la vitamina D3 que no requieren de la biotransformación en el hígado, tales como el 25(OH)D3 y el 1,25(OH)2D3. De este modo se puede aliviar las consecuencias relacionadas con el metabolismo de la Vitamina D3 cuando hay daño hepático, como puede ser la mala calidad de la cáscara.
Usar un secuestrante de micotoxinas que garantice al menos una buena neutralización de las Aflatoxinas en caso de estar presentes.
MEZCLA ÚNICA
MÁS FUERTE A TRAVÉS DE INNOVACIÓN
Propiedades desinfectantes aún más poderosas
El único biocida con registro EU-BPR en clasificación PT02, PT03, PT04 y PT05
Más sostenible y a prueba de futuro
PT02, PT03, PT04, PT05

*Intra Hydrocare tiene su propio registro EU-BPR para uso en ganadería. Con una clasificación PT05, Intra Hydrocare es el único biocida basado en peróxido de hidrógeno permitido para uso en agua potable hasta un dosis de 250 ml por 1.000 litros de agua mientras los animales están presentes. Esto hace Hydrocare único!

QUIERE SABER MÁS?

Pioneros en soluciones preparadas para el futuro
La suplementación de agentes lipotrópicos tales como Colina , Metionina, Betaína y Vitamina B12 ayudan a movilizar la grasa del hígado y apoyan la recuperación de las aves afectadas
Agregar en el agua o en el alimento, aditivos derivados de plantas tales como Silimarina (Cardo lechoso), Extracto de Cynara (Alcachofa), Romero, etc. son también una buena opción terapéutica para ayudar a recuperar el hígado.
A lo largo de su vida productiva, el estado del epitelio intestinal sufre una progresiva degradación como consecuencia, entre otras cosas, del empleo de dietas muy ricas en cenizas, que resultan ser abrasivas para el epitelio, por la acción prolongada de ciertas micotoxinas, aún en dosis muy bajas, o por el progresivo efecto de los factores antinutricionales de algunas materias primas.
Como consecuencia, las vellosidades intestinales pierden tamaño, las uniones firmes se deterioran, y la permeabilidad puede incrementarse.
Este aumento de la permeabilidad intestinal puede estar detrás de la aparición de problemas patológicos, o incluso de procesos zoonóticos en las gallinas. El riesgo de salmonelosis puede incrementarse de forma evidente en este periodo de final de vida, así como colisepticemias, cojeras de origen bacteriano, y otros procesos patológicos que incrementarán la mortalidad de las aves, reduciendo su rentabilidad.
Independientemente de esta posible mortalidad, un intestino deteriorado reducirá la capacidad de digestión y absorción de los nutrientes, específicamente el calcio, pero también aminoácidos o fuentes de energía, reduciendo la capacidad productiva de las aves.
Será, por tanto, de gran importancia para prolongar la vida comercial de las gallinas mejorar en lo posible el estado del intestino de estas, con el empleo de aditivos que reparen la pared intestinal (butirato puede ser un buen aliado), reduzcan el estrés osmótico (betaína, por ejemplo), mejoren el estado de las uniones firmes (minerales orgánicos pueden ir aquí) o permitan un mejor balance de la biota intestinal (pro y prebióticos, ciertos extractos vegetales, etc).
Pero no se nos debe olvidar que, en este periodo de la vida de las gallinas, la digestibilidad de la dieta será aún más importante que la concentración de la misma.
No se trata de poner en el pienso todos los nutrientes, incluso de forma excesiva, si no de asegurarnos que el animal será capaz de emplearlos.
Alimentación de ponedoras de larga vida productiva DESCÁRGALO EN PDF
